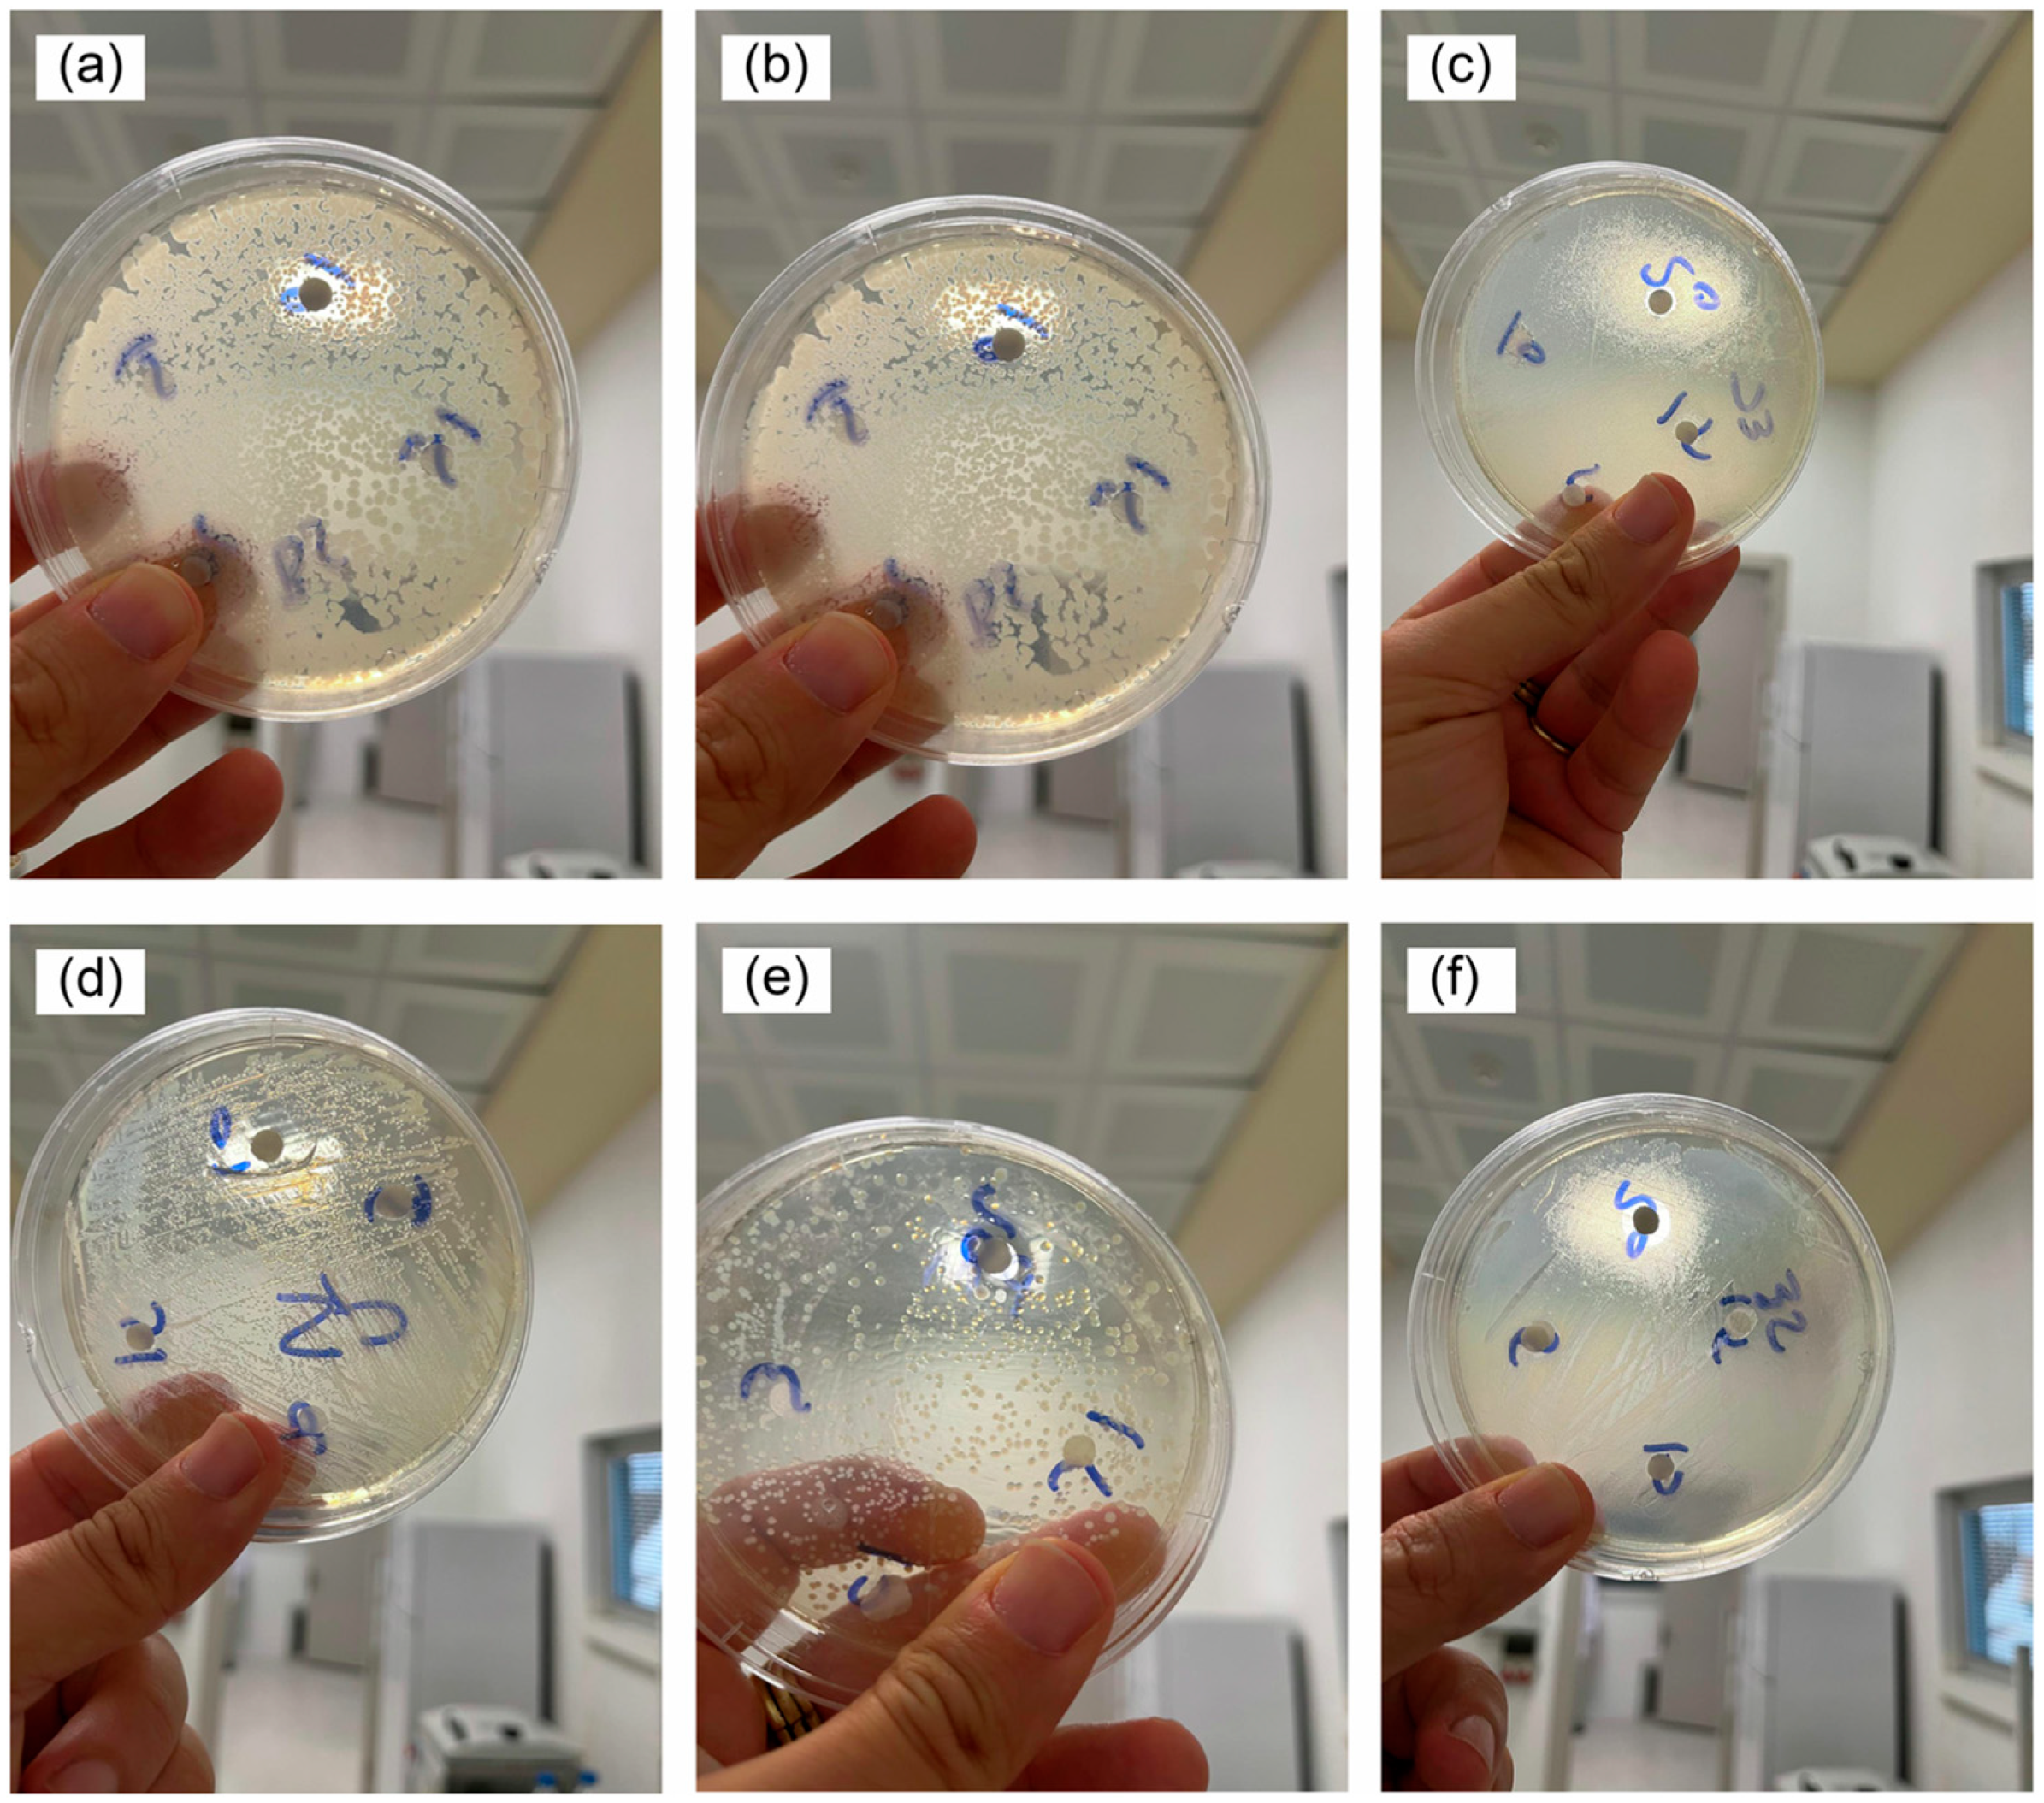
Inorganics 13 00268 g006 Inorganics 13 00268 g006

Abstract
In recent years, researchers have made great efforts to develop effective semiconductor photocatalysts to harness the visible spectrum of sunlight in photocatalytic applications. Bismuth vanadate, BiVO4, has emerged as one of the most promising candidates for photocatalytic applications among the few non-titania-based visible-light-driven semiconductor photocatalysts. BiVO4-based structures are intensively studied due to their exceptional ionic conductivity, photocatalytic behavior under ultra-violet and visible light, dielectric properties, ferroelastic and paraelastic phase transitions, and strong pigmentation. BiVO4 occurs in nature in three crystalline structures: orthorhombic pucherite, tetragonal dreyerite (tz), and monoclinic clinobisvanite (ms). All three crystal structures of BiVO4 are n-type semiconductors with corresponding energy gap values of 2.34, 2.40, and 2.90 eV, respectively. Different methods of synthesis have been reported for the preparation of BiVO4 structures of varying morphologies and sizes. The morphology of BiVO4 is strongly influenced by the preparation method and reaction parameters. A comprehensive systematic study of developments, preparation methods, structure, properties, and advances in different applications over the past decades in research on BiVO4-based structures will be described. Finally, the current challenges and future outlook of BiVO4-based structures will be highlighted, in the hope of contributing to guidelines for future applications.
1. Introduction
Water pollution is one of the most serious of all environmental problems, with critical effects on human life. Photocatalytic degradation technology, including advanced oxidation processes (AOPs), has become increasingly more useful, if not fully necessary, in the past few decades due to the larger presence of a wide range of organic and inorganic contaminants. Obtaining photocatalysts with ideal performances is the core problem for photocatalysis [1,2].
In recent decades, immense research attention has been focused on solving the pollution problem and developing different kinds of semiconductor photocatalysts. A series of photocatalysts have been designed for this purpose. Since the wide use of pure titania (TiO2) photocatalyst is limited to ultra-violet (UV)-driven processes and applications, alternative materials, including doped titania and composites, are being extensively explored. In particular, owing to their unique properties, Bi-based semiconductor photocatalytic materials have been widely studied [2]. Bismuth vanadate (BiVO4) shows great photocatalytic features that extend its use beyond the UV region due to its suitable band gap of 2.4 eV and favorable band edge alignment to water splitting. BiVO4 shows interesting physicochemical and dielectric properties, ferroelasticity, semiconductivity, and pigmentation. BiVO4 is polymorphous and occurs in three forms, which can be prepared synthetically: a scheelite-type structure with monoclinic (ms-) and tetragonal (ts-) systems, and a zircon-type structure with a tetragonal system (tz-). All three crystalline phases, ts-BiVO4, ms-BiVO4 and tz-BiVO4, are n-type semiconductors with band gap energies of 2.34, 2.40, and 2.90 eV, respectively. A fourth form, i.e., an orthorhombic structure of BiVO4, only occurs naturally as the mineral pucherite. As one of the promising non-titania visible-light-driven photocatalysts, ms-BiVO4 is studied intensively, and many ways to prepare ms-BiVO4 micro- and nanoparticles of varying morphologies and sizes have been tested. Also, due to its yellow color, non-toxic ms-BiVO4 is a good commercially available substitute to toxic cadmium- and lead-based yellow pigments [3,4].
Following the work of Kudo’s group in 1998 on the photocatalytic evolution of O2 under visible light irradiation of BiVO4 in aqueous AgNO3 solution [5,6,7], considerable research efforts have been devoted to BiVO4-based material. This material is an excellent candidate for use in photocatalytic water splitting and the photocatalytic degradation of air/water pollutants [8,9]. ms-BiVO4 is known to exhibit excellent photocatalytic activity under visible light; on the other hand, pure tz-BiVO4 has been studied to a much lesser extent as a photocatalyst [10,11,12].
In order to improve the photocatalytic performance of BiVO4, promoting the separation and transfer of photogenerated carriers, namely, the photoinduced electron (e−) and hole (h+) pairs, is necessary [4,13]. There are a lot of BiVO4-based heterojunction photocatalysts, including n-BiVO4@p-M [14], CaFe2O4/BiVO4 [15], TiO2/BiVO4 [16,17], rGO/BiVO4 [18], Bi2WO6/BiVO4 [19], Co3O4/BiVO4 [20], BiVO4/Bi4V2O11 [21], Ag3PO4/BiVO4 [22], Cu3Mo2O9/BiVO4 [23], BiVO4/CdS [24], Bi2S3/BiVO4/MgIn2S4 [25], and 2D Zn-MOF/BiVO4 [26], which have been developed for the photocatalytic decomposition of water, degradation of organic pollutants, and reduction of CO2 and heavy metal ions [27,28,29]. Enhanced photocatalytic performance has been reported for numerous doped BiVO4 materials with a zircon-type structure. Bi3+-based compounds can be easily doped with rare ions (RE3+) due to the equal valence and similar ionic radius. This means that RE3+ ions could be regarded as active co-catalysts and dopants to enhance the photocatalytic activity of BiVO4 [30,31,32]. Also, other dopants like Cu2+, Yb3+, Er3+, Nd3+, and Sm3+ ions can induce modifications of BiVO4 shape, increase its active area, and drastically change its optical properties, while transition metals molybdenum Mo6+ and tungsten W6+ can improve the electrical characteristics, electron mobility, and electrical conductivity of BiVO4 [33,34,35,36,37,38].
This review will be focused on the state of the art of the basic and applied research on BiVO4-based structures. A comprehensive systematic study of developments, preparation methods, structure, properties and advances in everyday applications over the past decades in research on BiVO4-based structures will be described.
2. Discussion
2.1. Advances in Synthesis of BiVO4-Based Structures
Different methods of synthesis have been reported for the preparation of monoclinic ms-BiVO4 or tz-BiVO4 with various morphologies and sizes. Several approaches have been used: co-precipitation and micro-emulsion [11,39,40,41,42,43,44,45,46], hydrothermal synthesis with and without the use of surfactant or template [47,48,49,50,51,52,53,54], rapid microwave-assisted processes and microwave-assisted hydrothermal methods [55,56,57,58,59,60,61,62], and solvothermal approaches [63,64,65,66,67,68,69]. Using a precipitation method, BiVO4 can be obtained from an aqueous solution of NH4VO3 and an aqueous nitric acid solution of Bi(NO3)3 [42,56,70,71,72] or from an aqueous nitric acid solution of Bi2O3 and V2O5 [12,73]. By using a microwave-assisted or hydrothermal technique, either an aqueous NaVO3 or NH4VO3 solution was mixed with nitric acid (HNO3) and Bi(NO3)3 solution, or mixture of the Bi2O3 and V2O5 in a molar ratio in HNO3 [60,74,75,76,77,78].
Several specialized methods have also been developed for the synthesis of BiVO4. These include: (i) a reaction involving layered potassium vanadate powders (KV3O8 and K3V5O14) and Bi(NO3)3 in aqueous solution, using a controlled vanadium-to-bismuth ratio [79]; (ii) a high-temperature colloidal synthesis in which Bi(NO3)3, NH4VO3, and polyethylene glycol (PEG) are dissolved in water [80]; and (iii) a low-temperature molten salt method employing a LiNO3–NaNO3 eutectic mixture (heated to 200 °C) as the solvent and a BiVO4 precursor, obtained as a precipitate from Bi(NO3)3 and NH4VO3 solutions, as the solute [81]. Structural phase transition in BiVO4 (from monoclinic to tetragonal) can occur under high pressure [82,83].
Bi(NO3)3·5H2O was used in most syntheses of BiVO4 as a bismuth precursor owing to its wide availability and cheapness. However, Bi(NO3)3·5H2O readily hydrolyzes into basic salts, BiO(NO3) and Bi(OH)2NO3, and other nitrates with numerous complicated compositions [84,85]. Recently, a novel and non-conventional synthesis method was attempted through a straightforward room-temperature non aqueous preparation method for producing nanocrystalline tz-BiVO4: NH4VO3 and Bi(NO3)3·5H2O were employed as precursors, with ethylene glycol (EG) serving as both the solvent and reaction medium for precipitation. Additionally, EG functions as a capping agent, limiting particle growth and preventing agglomeration [86,87,88].
Figure 1 schematically illustrates the formation process of the monoclinic/tetragonal BiVO4 heterostructure (m–t BiVO4), which involves nucleation followed by aggregation-driven growth. The phase transition from the monoclinic to the tetragonal structure is attributed to the stability of the 2-methoxyethanol (MEOH)–Bi complex formed during solvothermal treatment. In this process, Bi3+ ions coordinate with both the oxygen atom of the C–O–C bond and that of the O–H bond in the MEOH molecule. Notably, the relative intensity of the (200) diffraction peak, associated with the tetragonal phase, increases with prolonged thermal treatment [89].

Figure 1.
The formation mechanism of BiVO4 samples prepared using mixed solvents. The image was adapted from the reference [89], with permission from Elsevier.
2.2. Advances in the Study of Morphologies and Sizes of BiVO4-Based Structures
The morphology of BiVO4 material has a significant impact on its photocatalytic efficiency and other applications. The final morphology is strongly influenced by the preparation method and reaction parameters, such as the concentration and pH of precursor solutions, kind of solvent, reaction temperature, duration time of preparation, molar ratio of Bi3+/V5+, and the addition of surfactant and different dopant ions. The morphology of BiVO4 as a photocatalyst significantly enhances the performance of ceramic membranes in oily wastewater treatment [90]. The initial pH of the precursor solution is found to be a critical parameter in defining the phase and final morphology of BiVO4 particles [91,92,93,94,95]. The BiVO4 samples prepared by different methods of synthesis have different morphologies and sizes, such as (i) highly uniform monodisperse nanospheres of 125 nm in diameter [96]; (ii) irregular spheres (20–100 nm or few micrometers) [97,98]; (iii) hollow spheres (~700 nm) [99,100]; and (iv) nanorods (length of 300 nm) [101,102]. Other BiVO4 particles with unusual morphologies have been realized, including the following: needle (50–400 nm), irregular dog-bone (300–600 nm) [103], butterfly (4–10 µm) [63], leaf peanut (1–10 µm), roundish aggregates (1–5 µm) [57,104,105], polyhedral (6–8 µm) [45,106] and decagonal shape rods (2–3 μm) [107], potato- and broccoli-like (150–500 nm) [108], bowknot (5 µm), and dumbbell-like (~3 μm) [109]. Additionally, there are several publications about tz-BiVO4 spherical nanoparticles with diameters in the range of 10-40 nm and an ellipsoidal shape with a radius of about 20 nm [56,110]. Compared to larger particles or bulk material, nanostructured materials with larger surface areas showed significantly enhanced reactivity and higher photocatalytic activities for water splitting under UV light irradiation [13,111].
The field emission scanning electron microscopy (FESEM) technique was generally used to observe the morphologies of BiVO4 samples. Figure 2a,b show the prepared BiVO4 samples, including microspheres and dumbbell-like samples, according to the use of different molecular weights of PEG in the synthesis. The results indicated that BiVO4 with different microstructures can be selectively synthesized by simply changing the molecular weight of PEG. Also, the morphologies of samples can be controlled through varying the pH value of the hydrothermal process to obtain spindle and wheat-like BiVO4 samples, as shown in Figure 2c,d [109].

Figure 2.
FESEM images of the as-prepared BiVO4 samples: (a) spherical sample, (b) dumbbell-like sample, (c) spindle-like sample, and (d) wheat-like sample. Figure reproduced with modifications from the reference [109], with permission from Elsevier.
The scanning electron microscopy (SEM) images of the BiVO4 samples with different morphologies obtained for various Bi3+/V5+ molar ratios are shown in Figure 3. When the Bi3+/V5+ molar ratio is 1.0, micrometer-sized dumbbells (constructed from the assembly of many nanorods) with lengths of about 4–7 μm appear (Figure 3a,b), while when the Bi3+/V5+ molar ratio is 0.77, the obtained samples are composed of microrods with average diameter of about 1.4 μm (Figure 3c,d). As the molar ratio is reduced to 0.67 and 0.56, BiVO4 ellipsoids with a diameter of 1.0–1.3 μm and length of 1.5–2.0 μm, consisting of many small nanoparticles, and microspheres with an average diameter of 1.1 μm are obtained, respectively (Figure 3e,h). As the Bi3+/V5+ molar ratio is adjusted to 0.5, the BiVO4 particles with cake-like morphology, constituted by many small nanoparticles, and a uniform size of about 1.1 μm, are formed (Figure 3k,l). In order to obtain detailed information on the structure and morphologies of as-synthesized samples, transmission electron microscopy (TEM) can also be performed.

Figure 3.
SEM images of BiVO4 samples with different Bi3+/V5+ molar ratios: (a,b) 1.0, (c,d) 0.77, (e,f) 0.67, (g,h) 0.56, (i,j) 0.50, and (k,l) 0.40. The figure was adapted from the reference [112], with permission from Elsevier.
2.3. Crystal and Electronic Structure of BiVO4
This section discusses various crystal structures and the electronic structure of BiVO4 related to photoelectrochemical properties. As already mentioned, BiVO4 is an n-type semiconductor and can be synthesized in three crystal phases: monoclinic-scheelite (ms), tetragonal-zircon (tz), and tetragonal-scheelite (ts), which are sketched in Figure 4. The natural structure of BiVO4 as a mineral is pucherite with the orthorhombic crystal, and this structure cannot be obtained in the laboratory [113,114]. The scheelite structure has a tetragonal crystal system (space group: I41/a where a = b = 5.1470, and c = 11.7216 Å) or a monoclinic crystal system (space group: I2/b with a = 5.1935, b = 5.0898, c = 11.6972 Å, and β = 90.3871°) [115], whereas the zircon-type structure consists of a tetragonal crystal system (space group: I41/amd with a = b = 7.303 and c = 6.584 Å). In the BiVO4 scheelite structure, each Bi atom, similar to Gd3+ in GdVO4 matrix, [115] is coordinated by eight oxygen atoms from different VO4 tetrahedral units and each V atom is coordinated by four oxygen atoms at the tetrahedral site [116], as shown in Figure 4 from the left to the right side, where Bi and V centers are coordinated along the [001] direction. At the end of the Figure there are balls of different colors that represent Bi, V and oxygen atoms. Each oxygen atom is coordinated by two Bi and one V center, forming a three-dimensional network bridging Bi and V centers together. However, the monoclinic scheelite structure shows differences, such as more distortion in the local environment of Bi and V ions, two different V-O bond lengths (1.69 and 1.76 Å), and four different Bi-O bond lengths (2.35, 2.37, 2.52 and 2.63 Å) that lead to the loss of four-fold symmetry [116]. In the tetragonal scheelite structure, all four V-O bond lengths are equal to 1.73 Å, but two different Bi-O bond lengths (2.4 and 2.47 Å) exist [116]. The observed significant distortion in the monoclinic scheelite structure enhances the local polarization, leading to better electrons and hole separation and superior photo-electrocatalytic activity compared to the tetragonal scheelite structure [117]. The local environment of Bi and V centers for the zircon-type structure is shown in Figure 4, where eight oxygen atoms coordinate Bi through six different VO4 tetrahedral units because two VO4 tetrahedral units provide two oxygen atoms to the Bi atom. Each V atom is coordinated by four oxygen atoms [3].

Figure 4.
Graphic illustration of three crystal structures in BiVO4: monoclinic scheelite (I2/a), tetragonal scheelite (I41/a), and zircon-type tetragonal (I41/amd), respectively. The figure was adapted from the reference [82], with permission from the American Chemical Society.
The band gap energy of BiVO4 allows it to be active in the visible region, with values of 2.4 eV for the scheelite structure and 2.9 eV for the zircon-type structure. BiVO4 does not yet attain practical conversion efficiency. The most limiting factor for BiVO4 conversion efficiency is the fast recombination of photogenerated electron–hole pairs [118,119,120,121,122,123,124]. The density functional theory (DFT) calculations indicated changes in bandgap and density of states and showed that the smaller band gap of monoclinic bismuth vanadate, compared with the zircon type, comes from hybridization between the Bi 6s state and the O 2p states at the top of valence band [125]. The conduction band is primarily composed by V 3d states, with additional contribution of O 2p and Bi 6p orbitales [126]. The coupling of states results in an upward dispersion of the valence band and a lowering of the conduction band to a minimum, causing symmetric electron and hole masses, which facilitate a relatively efficient charge carrier separation and extraction [127]. The first-principles band structure calculations demonstrate the direct origin of the BiVO4 band gap [86,87,88].
3. Advances in Applications of BiVO4-Based Structures
3.1. Degradation of Organic Compounds: Role of BiVO4-Based Composite Photocatalysts
This section discusses the degradation of various organic compounds in the presence of BiVO4-based structures and composite photocatalysts. In recent years, researchers have made great efforts to develop effective semiconductor photocatalysts to harness the visible spectrum of sunlight in photocatalytic applications. A method for the degradation of toxic organic compounds/pollutants from the environment using semiconducting materials is an attractive approach. The nano-sized, ball-like structure of BiVO4 nanoparticles can act as a good photocatalyst, sensor, and heavy metal detector. Photocatalytic efficiency was assessed through degradation studies using methylene blue (MB) dye under visible light irradiation, demonstrating an impressive 93% degradation rate [4,78,128]. In the case of the BiVO4/graphene nanocomposite, effective degradation of methyl orange (MO) was spotted while the photocatalytic activity increased, resulting in different composites, after excitation of the BiVO4 photocatalyst and generation of electron–hole pairs [129]. Meanwhile, the BiVO4@MWCNTs photocatalysts were synthesized by incorporation of the synthesized BiVO4 nanoparticles with various percentages of multi-walled carbon nanotubes (MWCNTs) and were used as probes for the photocatalytic removal of atrazine (AZ) under visible light illumination [130]. The p-n heterojunction photocatalyst prepared by decorating CuO micro-planks with spherically shaped BiVO4 was proven to be efficient in the degradation of MB and Cr(VI) reduction under visible light irradiation. Moreover, two-dimensional (2D) TiO2 aerogel powder decorated with BiVO4 (TiO2/BiVO4) was used for the reduction of toxic Cr(VI) to Cr(III) [131,132]. Bi/BiVO4 microstructures with a novel hollow chainlike morphology were successfully fabricated. Owing to the synergistic interaction between them, improved photocatalytic activity was observed for the photodegradation of Rhodamine B (RhB) under visible-light illumination, compared to the single photocatalytic actions of BiVO4 and Bi [133]. The synergistic effects of oxygen vacancies and built-in electric fields in GdCrO3/BiVO4 and 2D/2D InVO4/BiVO4 heterostructures effectively enhanced their photocatalytic performance for nitrate reduction in water and improved their photoelectrochemical activity, respectively, by facilitating charge separation and suppressing recombination [134,135].
Pharmaceuticals and antibiotics have been classified as critical water pollutants. In order to find a suitable technique for removing them from contaminated water, the photoelectrocatalytic oxidation method has attracted much attention in recent years. The BiVO4/Ag2S p-n heterojunction fabricated by using electrodeposition and successive ionic layer adsorption on fluorine-doped tin oxide glass (FTO) or graphitic carbon nitride (g-C3N4) decorated with Pt@BiVO4 have been used for the degradation of ciprofloxacin and sulfamethoxazole [136,137].
BiVO4 has also been used in a tribocatalysis experiment utilizing magnetic stirring for the disintegration of the MB dye [138]. Figure 5 shows the UV–visible absorption peak spectra related to the degradation of MB dye in 24 h, as a function of the magnetic stirring rotation speed.

Figure 5.
Absorbance spectra of MB dye in 24 h using 1 g of BiVO4 at different rotational speeds: (a) 300 rpm, (b) 500 rpm, (c) 700 rpm, and (d) without any catalytic dose (control) at 700 rpm. The figure was adapted from the reference [138], with permission from Elsevier.
The degradation rate efficiency (D) can be calculated using Equation (1). The degradation of a dye catalyzed by BiVO4 is analyzed using the pseudo-first-order kinetics model (Equation (2)), and the rate constant of dye degradation is calculated [139]:
where C0 is the initial solute concentration,
is the solute concentration at a certain reaction time (t), and k is the pseudo-first-order rate constant.
The sonocatalysis activity of BiVO4/FeVO4 composites was also investigated by analyzing the removal process of the drug model tetracycline (TETR). In comparation to BiVO4, the composites exhibited significantly enhanced sonocatalytic activity in degrading TETR due to the formation of type-II heterojunctions, which promoted effective electron–hole pair separation [140]. The improvement in photocatalytic activity is attributed to morphology, different dopant ions, light absorption efficiency, and the reduced recombination rate of the excited charge carriers. A comparison of the photocatalytic performances of BiVO4 with different morphologies and other catalysts—TiO2, g-C3N4/TiO2, V2O5/TiO2, Nd3+-TiO2, Nb2O5, In2O3-TiO2, ZnO:Eu—under UV and visible light irradiation is presented in Table 1.

Table 1.
Comparison of photocatalytic performances/degradation efficiencies of BiVO4 with different morphologies and other catalysts under ultra-violet (UV) and visible (Vis) light irradiation.
3.2. Antibacterial Activity of the BiVO4-Based Structures
BiVO4 has also been studied as non-toxic material for potential biomedical applications due to its antibacterial activity against various pathogenic bacteria. The antibacterial activity of this material was estimated by using the pathogenic microbes Escherichia coli (E. coli) and Staphylococcus aureus (S. aureus) [152]. The photo-induced high antibacterial activity of monoclinic BiVO4 nanoparticles has also been tested in antibacterial efficiency and environmental remediation applications based on their photocatalytic activity targeting organic dyes and different water pollutants [153]. BiVO4@activated carbon fiber can be used as an antibacterial agent against both E. coli and S. aureus, with enhanced recyclability [154]. Antibacterial efficacy was assessed against by Gram-positive (E. coli and S. aureus) and Gram-negative (E. coli and Pseudomonas aeruginosa) bacteria using BiVO4 and Ta-doped BiVO4 nanoparticles at various concentrations [155]. Bacterial cultures were incubated with Ta-BiVO4 nanoparticles under visible light illumination and in the dark for the antibacterial assays. The antibacterial activity of Ta-doped BiVO4 nanoparticles was successfully assessed, indicating their potential as strong antibacterial agents against both Gram-positive and Gram-negative bacteria [156,157]. The antibacterial activity of BiVO4 nanoparticles against six different bacterial strains, evaluated using the disc diffusion method, is presented in Figure 6.

Figure 6.
Antibacterial activity of BiVO4 nanoparticles against (a) B. subtilis, (b) B. cereus, (c) E. coli, (d) P. aeruginosa, (e) S. aureus, and (f) S. enteritidis. The figure was adapted from the reference [156] under a Creative Commons 4.0 License.
N-, Cr-, and N/Cr-doped TiO2 nanoparticles were evaluated against Escherichia coli under dark conditions and visible light irradiation. The results showed a clear antibacterial effect, attributed to the high degree of dispersion and enhanced electrostatic interactions [158]. Additionally, Ag-doped N-TiO2 demonstrated antibacterial effects against selected Gram-negative bacteria commonly found in the marine environment [159]. On the other hand, antibacterial studies of Nb2O5-doped bioactive glasses against E. coli and S. aureus showed maximal bacterial killing in samples containing 4.0 mol% of Nb2O5. The results indicated that Nb2O5 not only enhanced bioactivity potential but also exhibited antimicrobial activity [160]. ZnO-based materials also showed antibacterial activity against different types of Gram-positive bacteria (Bacillus manliponensis, Micrococcus luteus, Staphylococcus aureus) and Gram-negative bacteria (Escherichia coli). The results demonstrated that the generated O2− radicals played a more critical role in antibacterial activity than particle shape [161].
The antibacterial activity and the generation of reactive oxygen species (ROS) of te BiOCl/BiVO4 heterojunction can be improved compared to BiVO4 [162]. The ROS produced in the PDA-rGO/BiVO4 heterojunction blocked the transmembrane transport of bacteria, as confirmed by using ROS fluorescence detection [163]. The antibacterial and UV-protection properties of the prepared CuO/BiVO4@cotton were also studied. The CuO/BiVO4 nanocomposite overcomes the low quantum efficiency of pure BiVO4. The nanocomposite exhibits very good recyclability as a photocatalyst on cotton fabrics/flexible textiles, with multiple functions in addition to the degradation of pollutants from waste water [164]. The normal, inactivated tested bacterial strains with smooth surfaces are attributed to the production of ROS species such as OH and O2−, which easily cross the cell membrane and enter the interior of the strains [165,166].
3.3. Application of the BiVO4-Based Structures in the Food Industry
BiVO4 is an ideal starting material for antioxidant surveillance under visible light irradiation. BiVO4, however, is usually doped, due to unsatisfactory charge collection and utilization in practical applications, to exploit the effects of dopants on photocatalytic behavior under visible light illumination. The substitution of Bi3+ or V5+ ions with other M3+ or M6+ metal ions leads to significant changes in physical properties, such as structural distortions of the crystal unit, formation of a new phases, and evident changes in morphological, optical, and electrical properties due to the different ionic radii of the involved ions. This proof of concept is useful for the detection of antioxidant capacity in the foodstuff industry, opening up a bright future in cosmetic and healthcare areas [167]. A label-free photoelectrochemical (PEC) sensor based on BiVO4@GO composites was prepared for the detection of antioxidants and the antioxidant capacity of food. Large surface area and good conductivity make the BiVO4@GO composites a unique, promising sensor for the evaluation of antioxidant capacity in food, which will help the organism obtain enough antioxidants to defend against free radicals [168], while the crystal-reconstructed BiVO4 PEC biosensor can be applied in the fields of multi-tumor or viral biomarker detection [169]. The composition and pH of the electrolyte, applied bias, as well as surface morphology of the photoactive layer can have a significant effect on the selectivity and use of the PEC sensors [170]. The synthesized BiVO4 PEC sensor, with a unique carnation-like morphology and high specific surface area, demonstrated high potential for Cr(VI) detection, with a wide linear range of 2–210 μM and a very low limit of detection (LOD) of 0.01 μM. This BiVO3-based PEC sensor can be used, for instance, in food safety monitoring for Cr(VI) detection in peanuts, rice, soil and tap water, with satisfactory recovery rates of 90.3 to 103.0% [171].
Propyl gallate is widely used in the food industry as one of the most important additives to prevent oxidation processes. Synthesized Cu3(PO4)2/BiVO4 composites and the GCE/BiVO4/ZrO2@graphene electrode can be used for the determination of propyl gallate and of acetaminophen, phenylephrine hydrochloride, and cytosine, respectively, in different food products. These materials are beneficial for food quality monitoring, reduce the risk of propyl gallate overuse in food, and are recommended for potential medical applications [172,173]. A new photosensitive sensor was developed for the successful electrochemical analysis of quercetin from natural samples using an ITO/MWCNT@PC@BiVO4 composite due to the photosensitivity and stable structure of BiVO4, high electron permeability of MWCNT, and advantageous electron transfer [174,175]. Electrochemical and Surface-Enhanced Raman Spectroscopy (SERS) sensors based on TiO2 or Ag-doped TiO2 nanostructured materials have been broadly applied for detecting traces of cypermethrin pesticide, tartrazine, tryptamine, saccharin sodium, furazolidone, bisphenol A (BPA), histamine, and other contaminants in complex food samples [176,177,178]. On other hand, Pd-ZnO nanoflowers have shown to act as promising gas sensors for the detection of meat spoilage. Nb2O5 has been also used as a gas sensor in detecting ethanol, H2S, H2, NOx, CO, and VOCs, exhibiting effective potential for applications in environmental monitoring, industrial processes, food safety, biomedicine, fuel processing, and automotive domains [179,180,181].
The synergic effects between g-C3N4 and BiVO4 in the g-C3N4/BiVO4 composites, used as a photoactive material, produced an increase in photocurrent response after the composites were fixed on the surface of the FTO electrode [182]. The illustration of the g-C3N4/BiVO4 PEC sensor for tetracycline (TC) residue detection in food samples (honey) and animal products (kidney, milk, pork) is presented in Figure 7.

Figure 7.
Schematic illustration of g-C3N4/BiVO4 PEC sensor for tetracycline detection in food samples. Figure reproduced from the reference [182], with permission from Elsevier.
3.4. Applications of BiVO4-Based Structures as Photoelectrodes in Water Splitting
In recent years, in addition to their application in environmental protection for organic pollutant degradation, antibacterial properties, and food safety monitoring, BiVO4-based structures have also attracted attention for their multipotential applications [183]. BiVO4-based photoelectrodes show great potential in several practical applications. Due to good visible light responsiveness and stable optoelectrical properties, BiVO4-based structures can be widely used for efficient water splitting and hydrogen production [184,185].
To fabricate photoanodes with large areas, possessing excellent and uniform PEC activities, it is very important to include defect states of the material; thus, highly efficient BiVO4 photoanodes containing adjustable concentrations of bismuth and oxygen vacancies, Bivac. and Ovac, were fabricated [186]. With the aim to promote charge separation in the bulk material, a BiVO4-based photoanode with a lattice strain was prepared by generating Bi vacancies [187]. In addition, BiVO4 photoanodes were also used in PEC cells for the production of various chemicals, as well as for PEC water splitting [188].
Water splitting based on numerous visible-light-responsive photocatalysts is one of the most important and cost-effective approaches for the conversion of solar energy into clean and renewable hydrogen energy and the production of green H2 on a large scale. This result can be easily achieved through a one-step excitation system using a single photocatalyst or Z-scheme strategies based on a pair of photocatalysts [189,190]. Photoelectrochemical water splitting techniques often require a corrosive electrolyte, limiting their stability and environmental sustainability; an alternative method for the clean production of hydrogen can be obtained directly from sunlight and water by photocatalytic water splitting [191].
The BiVO4 material possesses several limiting parameters, including low charge mobility, high bulk recombination rates, and oxygen evolution reaction (OER) kinetics at the surface, which affects its use as a high-performance PEC photoanode for solar water splitting. Numerous strategies have been applied to improve this performance, and texture engineering has emerged as a promising approach. One approach for improving PEC efficiency is based on controlling the crystallographic orientation and exposed facets, which enhances charge transport and reduces surface recombination [192]. Following this direction in preparation, octadecahedral-BiVO4 photoanodes were successfully produced with exposed {040}, {011} and high-reactivity {121} facets. It was shown that the charge separation dramatically improved, and the {121} facets showed better oxygen evolution reaction (OER) activity for triggering water oxidation than the {040} and {011} facets [193]. Other approaches for improving the PEC efficiency are based on different morphologies, doping, modification, and making different BiVO4-based composites. BiVO4 nanowires, due to negative surface photovoltage signals, are suitable for the construction of membranes for solar energy conversion [194]. A suitable doping concentration of Cu in BiVO4 resulted in enhanced electronic conductivity and improved charge transfer dynamics compared to un-doped BiVO4 [195,196].
Multi-interfacial optimization of BiVO4-based composites to improve charge separation efficiency, due to synergistic effects within the material matrix, has emerged as a main strategy for improving PEC performance [197]. Ti3C2 quantum-dot-modified BiVO4 photoelectrodes, BiVO4/Ti3C2 QDs, for water-splitting H2 production, showed improved photoelectron–hole pair separation and photocurrent density, about 2.5 times higher than that of bare BiVO4 [198]. Additionally, due to the synergistic effect of CuSCN and Ni: FeOOH, the photocurrent density of the optimized BiVO4/CuSCN/Ni: FeOOH photoanode is 3.39 times higher than that of pure BiVO4 [199]. A similar ratio in photocurrent density is obtained for the photoanodes BiVO4/Co,Fe-NTMP (nitrilotris-methylenephosphonic acid) and BiVO4 [200]. The RGO@g-C3N4/BiVO4 photocatalysts have dual applications in photoelectrocatalytic H2 production and antibiotic tetracycline chloride degradation. Triple composites of g-C3N4/RGO/BiVO4, formed by the synergistic effect between BiVO4, RGO, and g-C3N4, show significant photocatalytic activity compared to pure BiVO4 or g-C3N4 [201]. Recently, an Ag/BiVO4 composite for application in an H2O2 fuel cell was fabricated. Compared with BiVO4 nanoplates, the Ag/BiVO4 composite had a narrower band gap, enhanced visible light absorption and photocatalytic activity, and it provided a new strategy model for the efficient conversion and utilization of solar energy [202]. On the other hand, 10 cm2 perovskite–BiVO4 tandem PEC devices were fabricated with a selective Cu92In8 alloy catalyst which could demonstrate synthesis gas (syngas) production coupled to O2 evolution over 36 h [203].
An example of a photocatalytic system based on BiVO4 composites is presented in the scheme shown in Figure 8. The system is composed of two separate reaction parts: a hydrogen evolution cell containing halide perovskite photocatalysts (MoSe2-loaded CH(NH2)2PbBr3-xIx) and an oxygen evolution cell containing NiFe-layered double hydroxide-modified BiVO4 photocatalysts mediated by the I3−/I− redox shuttle [204].

Figure 8.
Schematic illustration of the Z-scheme solar water-splitting system with separated H2 and O2 production. The net reaction is water splitting to produce H2 and O2 mediated by the I3−/I− redox shuttle. (HER—hydrogen evolution reaction; OER—oxygen evolution reaction; NiFe-LDH/BiVO4 I− I3− I− oxidation H2 MoSe2 H+ MoSe2/FPBI HER hν represents NiFe-layered double hydroxide-modified BiVO4. FPBI/MoSe2 represents FAPbBr3-xIx (FPBI, FA = CH(NH2)2+) loaded with molybdenum selenide, CC—carbon cloth, and FTO—fluorine-doped tin-oxide-coated glass). The figure is reproduced from the reference [204] under a Creative Commons 4.0 License.
The summarized performances of BiVO4 reported on the literature are highlighted and given in Table 2.

Table 2.
Summarized performances of BiVO4 materials reported in the literature.
4. Conclusions
This review has provided a systematic study and a related bibliography concerning developments, preparation methods, structures, properties, applications, and recent advances of the research on BiVO4-based structures. Compared with the limitations of pure TiO2 in UV-range applications, BiVO4 offers superior photocatalytic properties operating beyond the UV region. Its narrow band gap of 2.4 eV makes it particularly favorable for water splitting. In addition, BiVO4 exhibits excellent physicochemical and dielectric properties. Moreover, due to its yellow color and non-toxic nature, monoclinic scheelite BiVO4 represents a commercially viable alternative to toxic cadmium- and lead-based yellow pigments.
A detailed discussion was presented regarding the preparation approaches, processes, morphology, crystal and electronic structure, performance, and applications of BiVO4-based structures. The morphology of BiVO4 material has a significant impact on its photocatalytic efficiency. The final morphology is strongly influenced by the synthesis preparation method and reaction parameters, such as concentration and pH value of precursor solutions, kind of solvent, reaction temperature, preparation time, Bi3+/V5+ molar ratio, surfactant addition, and the presence of different dopant ions. The enhanced photocatalytic activity can be attributed to morphology, improved light absorption due to a lower band gap, and reduced recombination rate of excited charge carriers.
A method of degrading toxic organic compounds/pollutants in the environment using semiconducting materials constitutes a very attractive approach. Photodegradation of various organic compounds like methylene blue, Rhodamine B, and atrazine, as well as pharmaceutical species, such as ciprofloxacin and sulfamethoxazole, in the presence of BiVO4-based photocatalysts under visible light irradiation was explained in detail. BiVO4 has been studied as a non-toxic material with high potential for biomedical applications due to its antibacterial activity against various pathogenic bacteria microbes, e.g., Escherichia coli (E. coli) and Staphylococcus aureus (S. aureus). Additionally, BiVO4 has been studied as an ideal starting material for antioxidant surveillance under visible light irradiation to assess the antioxidant capacity of foodstuffs, opening up a bright future for these materials in cosmetic and healthcare applications as well. Moreover, BiVO4 as biosensor can be applied in the fields of multi-tumor or viral biomarker detection. Due to good visible light responsiveness and stable optoelectrical properties, BiVO4-based structures have also been studied as photoanodes for efficient water splitting and hydrogen production, as well as high-performance photoelectrochemical (PEC) sensors.
Despite its many advantages, such as a narrow band gap (2.40 eV for ms-BiVO4), yellow color, pigmentation, cost-effectiveness, and ease of synthesis, the most dominant disadvantages of BiVO4 are based on the fast recombination of photogenerated electron–hole pairs.
Looking into the future, research on BiVO4-based structures should be focused on developing novel synthesis techniques for nanostructure design and for industrial-scale production processes, with the aim of improving, in particular, charge separation efficiency, photocatalytic performance, antibacterial activity, and photoelectrochemical efficiency. These goals may be achieved by controlling the crystallographic orientation and long-term stability of BiVO4-based photoanodes. With reference to the great current concern for the preservation of the environment, the continuous exploration and optimization of BiVO4-based structures in the field of PEC water splitting will significantly contribute to the development of a global system towards clean, renewable, and sustainable energies.
Author Contributions
Conceptualization, D.M. and M.F.; methodology, D.M.; software, G.C.R. and M.F.; validation, D.M., G.C.R., and M.F.; resources, D.M. and M.F.; writing—original draft preparation, D.M. and M.F.; writing—review and editing, D.M., G.C.R., and M.F.; funding acquisition, D.M. and M.F. All authors have read and agreed to the published version of the manuscript.
Funding
This research was supported by the Ministry of Science, Technological Development and Innovation of the Republic of Serbia (grant number 451-03-136/2025-03/200017).
Institutional Review Board Statement
Not applicable.
Informed Consent Statement
Not applicable.
Data Availability Statement
No new data were created or analyzed in this study. Data sharing is not applicable to this article.
Conflicts of Interest
The authors declare no conflicts of interest.
References
- Khader, E.H.; Muslim, S.A.; Saady, N.M.C.N.; Ali, S.; Salih, I.K.; Mohammed, T.J.; Albayati, T.M.; Zendehboudi, S. Recent advances in photocatalytic advanced oxidation processes for organic compound degradation: A review. Desalination Water Treat. 2024, 318, 100384. [Google Scholar] [CrossRef]
- Yang, F.; Yu, X.; Wang, K.; Liu, Z.; Gao, Z.; Zhang, T.; Niu, J.; Zhao, J.; Yao, B. Photocatalytic degradation of methylene blue over BiVO4/BiPO4/rGO heterojunctions and their artificial neural network model. J. Alloys Compd. 2023, 960, 170716. [Google Scholar] [CrossRef]
- Park, Y.; McDonald, K.J.; Choi, K.-S. Progress in bismuth vanadate photoanodes for use in solar water oxidation. Chem. Soc. Rev. 2013, 42, 2321–2337. [Google Scholar] [CrossRef]
- Nguyen, T.D.; Nguyen, V.H.; Nanda, S.; Vo, D.-V.N.; Nguyen, V.H.; Tran, T.V.; Nong, L.X.; Nguyen, T.T.; Bach, L.-G.; Abdullah, B.; et al. BiVO4 photocatalysis design and applications to oxygen production and degradation of organic compounds: A review. Environ. Chem. Lett. 2020, 18, 1779–1801. [Google Scholar] [CrossRef]
- Kudo, A.; Ueda, K.; Kato, H.; Mikami, I. Photocatalytic O2 evolution under visible light irradiation on BiVO4 in aqueous AgNO3 solution. Catal. Lett. 1998, 53, 229–230. [Google Scholar] [CrossRef]
- Suarez, C.M.; Hernández, S.; Russo, N. BiVO4 as photocatalyst for solar fuels production through water splitting: A short review. Appl. Catal. A Gen. 2015, 504, 158–170. [Google Scholar] [CrossRef]
- Li, Z.; Luo, W.; Zhang, M.; Feng, J.; Zou, Z. Photoelectrochemical cells for solar hydrogen production: Current state of promissing photoelectrodes, methods to improve their properties, and outlook. Energy Environ. Sci. 2013, 6, 347–370. [Google Scholar] [CrossRef]
- Qiao, R.; Mao, M.; Hu, E.; Zhong, Y.; Ning, J.; Hu, Y. Facile formation of mesoporous BiVO4/Ag/AgCl heterostructured microspheres with enhanced visible-light photoactivity. Inorg. Chem. 2015, 54, 9033–9039. [Google Scholar] [CrossRef]
- Thalluri, S.M.; Hernández, S.; Bensaid, S.; Saracco, G.; Russo, N. Green-synthesized W- and Mo-doped BiVO4 oriented along the {0 4 0} facet with enhanced activity for the sun-driven water oxidation. Appl. Catal. B Environ. 2016, 180, 630–636. [Google Scholar] [CrossRef]
- Nagabhushana, G.P.; Tavakoli, A.H.; Navrotsky, A. Energetics of bismuth vanadate. J. Solid State Chem. 2015, 225, 187–192. [Google Scholar] [CrossRef]
- Saison, T.; Chemin, N.; Chanéac, C.; Durupthy, O.; Mariey, L.; Maugé, F.; Brezová, V.; Jolivet, J.-P. New insights into BiVO4 properties as visible light photocatalyst. J. Phys. Chem. C. 2015, 119, 12967–12977. [Google Scholar] [CrossRef]
- Iwase, A.; Kato, H.; Kudo, A. A simple preparation method of visible-light-driven BiVO4 photocatalysts from oxide starting materials (Bi2O3 and V2O5) and their photocatalytic activities. J. Sol. Energy Eng. 2010, 132, 021106. [Google Scholar] [CrossRef]
- Zhong, X.; Li, Y.; Wu, H.; Xie, R. Recent progress in BiVO4-based heterojunction nanomaterials for photocatalytic applications. Mater. Sci. Eng. B 2023, 289, 116278. [Google Scholar] [CrossRef]
- Zhao, W.; Liu, Y.; Wei, Z.; Yang, S.; He, H.; Sun, C. Fabrication of a novel p–n heterojunction photocatalyst n-BiVO4@p-MoS2 with core–shell structure and its excellent visible-light photocatalytic reduction and oxidation activities. Appl. Catal. B-Environ. 2016, 185, 242–252. [Google Scholar] [CrossRef]
- Srinivasan, N.; Sakai, E.; Miyauchi, M. Balanced excitation between two semiconductors in bulk heterojunction Z-scheme system for overall water splitting. ACS Catal. 2016, 6, 2197–2200. [Google Scholar] [CrossRef]
- Xie, M.; Feng, Y.; Fu, X.; Luan, P.; Jing, L. Phosphate-bridged TiO2-BiVO4 nanocomposites with exceptional visible activities for photocatalytic water splitting. J. Alloys Compd. 2015, 631, 120–124. [Google Scholar] [CrossRef]
- Lv, Y.-R.; Liu, C.-J.; He, R.-K.; Li, X.; Xu, Y.-H. BiVO4/TiO2 heterojunction with enhanced photocatalytic activities and photoelectochemistry performances under visible light illumination. Mater. Res. Bull. 2019, 117, 35–40. [Google Scholar] [CrossRef]
- Wang, Y.; Wang, W.; Mao, H.; Lu, Y.; Lu, J.; Huang, J.; Ye, Z.; Lu, B. Electrostatic self-assembly of BiVO4-reduced graphene oxide nanocomposites for highly efficient visible light photocatalytic activities. ACS Appl. Mater. Interfaces 2014, 6, 12698–12706. [Google Scholar] [CrossRef]
- Phu, N.D.; Hoang, L.H.; Guo, P.-C.; Chen, X.-B.; Chou, W.C. Study of photocatalytic activities of Bi2WO6/BiVO4 nanocomposites. J. Sol-Gel Sci. Technol. 2017, 83, 640–646. [Google Scholar] [CrossRef]
- Cai, L.; Kisch, H. Visible light induced photoelectrochemical properties of n-BiVO4 and n-BiVO4/p-Co3O4. Phys. Chem. C 2008, 112, 548–554. [Google Scholar] [CrossRef]
- Li, J.; Lu, P.; Deng, W.; Zeng, Z.; Lin, L.; Zhao, G. Facile synthesis of sheet-like BiVO4/Bi4V2O11 composite for enhanced photocatalytic properties. Mater. Chem. Phys. 2020, 254, 123489. [Google Scholar] [CrossRef]
- Qi, X.; Gu, M.; Zhu, X.; Wu, J.; Wu, Q.; Long, H.; He, K. Controlled synthesis of Ag3PO4/BiVO4 composites with enhanced visible-light photocatalytic performance for the degradation of RhB and 2, 4-DCP. Mater. Res. Bull. 2016, 80, 215–222. [Google Scholar] [CrossRef]
- Xiong, B.; Wu, Y.; Du, J.; Li, J.; Liu, B.; Ke, G.; He, H.; Zhou, Y. Cu3Mo2O9/BiVO4 heterojunction films with integrated thermodynamic and kinetic advantages for solar water oxidation. ACS Sustain. Chem. Eng. 2020, 8, 14082–14090. [Google Scholar] [CrossRef]
- Zhang, T.; Wang, X.; Sun, Z.; Liang, Q.; Zhou, M.; Xu, S.; Li, Z.; Sun, D. Fabrication and efficient photocatalytic dye degradation over Z-scheme-based BiVO4/CdS heterojunction under visible-light irradiation. J. Mater. Sci. Mater. Electron. 2020, 31, 15742–15750. [Google Scholar] [CrossRef]
- Guo, Y.; Ao, Y.; Wang, P.; Wang, C. Mediator-free direct dual-Z-scheme Bi2S3/BiVO4/MgIn2S4 composite photocatalysts with enhanced visible-light-driven performance towards carbamazepine degradation. Appl. Catal. B-Environ. 2019, 254, 479–490. [Google Scholar] [CrossRef]
- Zhao, Z.; Bian, J.; Zhao, L.; Wu, H.; Xu, S.; Sun, L.; Li, Z.; Zhang, Z.; Jing, L. Construction of 2D Zn-MOF/BiVO4 S-scheme heterojunction for efficient photocatalytic CO2 conversion under visible light irradiation. Chin. J. Catal. 2022, 43, 1331–1340. [Google Scholar] [CrossRef]
- Song, A.; Zhang, Y.; Li, Z.; Hu, J. BiVO4/CuBi2O4 heterojunction photoanodes with enhanced charge separation for efficient photoelectrochemical water splitting. Mater. Sci. Eng. B 2024, 302, 117241. [Google Scholar] [CrossRef]
- Gao, F.; Yang, H.; Nan, C.; Zhou, W.; Gao, N.; Jia, Y.; Zhang, Y.; Chen, R. Efficient CO2 reduction to formate using a Cu-doped BiVO4 electrocathode in a WO3 photoanode-assisted photoelectrocatalytic system. J. Electroanal. Chem. 2023, 930, 117146. [Google Scholar] [CrossRef]
- Ghaware, R.C.; Birajdar, N.B.; Kamble, G.S.; Kolekar, S.S. Degradation of organic Pollutant by using of BiVO4–NiFe2O4 heterostructure photocatalyst under visible light irradiation: Assessment of detoxicity study using Cirrhinus mrigala. Langmuir 2024, 40, 14426–14439. [Google Scholar] [CrossRef] [PubMed]
- Xu, H.; Wu, C.; Li, H.; Chu, J.; Sun, G.; Xu, Y.; Yan, Y. Synthesis, characterization and photocatalytic activities of rare earth-loaded BiVO4 catalysts. Appl. Surf. Sci. 2009, 256, 597–602. [Google Scholar] [CrossRef]
- Wang, M.; Wu, L.; Zhang, F.; Gao, L.; Geng, L.; Ge, J.; Tian, K.; Chai, H.; Niu, H.; Liu, Y.; et al. Doping with rare earth el-ements and loading cocatalysts to improve the solar water splitting performance of BiVO4. Inorganics 2023, 11, 203. [Google Scholar] [CrossRef]
- Guardiano, M.G.; Gonzaga, I.M.D.; Ribeiro, L.K.; da Silva, A.C.V.; Mascaro, L.H. Gd-BiVO4: An efficient photoanode for pharmaceuticals degradation in contaminated waters via solar photoelectrocatalysis. J. Chem. Eng. 2025, 503, 158463. [Google Scholar] [CrossRef]
- Liu, B.; Yan, X.; Yan, H.; Yao, Y.; Cai, Y.; Wei, J.; Chen, S.; Xu, X.; Li, L. Preparation and characterization of Mo doped in BiVO4 with enhanced photocatalytic properties. Materials 2017, 10, 976. [Google Scholar] [CrossRef]
- Su, W.; Lu, Z.; Shi, Q.; Cheng, C.; Liu, C.; Lu, C.; Xie, H.; Lu, B.; Huang, K.; Xu, M.; et al. Surface states of Mo-doped BiVO4 nanoparticle-based photoanodes for photoelectrochemical degradation of chloramphenicol. ACS Appl. Nano Mater. 2024, 7, 14232–14241. [Google Scholar] [CrossRef]
- Wang, G.-L.; Shan, L.-W.; Wu, Z.; Dong, L.-M. Enhanced photocatalytic properties of molybdenum-doped BiVO4 prepared by sol–gel method. Rare Met. 2017, 36, 129–133. [Google Scholar] [CrossRef]
- Cen, J.; Li, S.; Zheng, J.; Pan, F. Electron polarons in the subsurface layer of Mo/W-doped BiVO4 surfaces. RSC Adv. 2019, 9, 819–823. [Google Scholar] [CrossRef]
- Kubendhiran, S.; Chung, R.-J.; Yougbaré, S.; Lin, L.-Y. Rational design of W-doped BiVO4 photoanode coupled with FeOOH for highly efficient photoelectrochemical catalyzing water oxidation. Int. J. Hydrogen Energy 2022, 47, 27012–27022. [Google Scholar] [CrossRef]
- Lalrindiki, F.; Singh, N.P.; Singh, N.M. A review of synthesis, photocatalytic, photoluminescence and antibacterial properties of bismuth vanadate-based nanomaterial. Inorg. Chem. Commun. 2024, 168, 112846. [Google Scholar] [CrossRef]
- Fan, H.; Jiang, T.; Li, H.; Wang, D.; Wang, L.; Zhai, J.; He, D.; Wang, P.; Xie, T. Effect of BiVO4 crystalline phases on the photoinduced carriers behavior and photocatalytic activity. J. Phys. Chem. C. 2012, 116, 2425–2430. [Google Scholar] [CrossRef]
- Cao, X.; Gu, Y.; Tian, H.; Fang, Y.; Johnson, D.; Ren, Z.; Chen, C.; Huang, Y. Microemulsion synthesis of ms/tz-BiVO4 composites: The effect of pH on crystal structure and photocatalytic performance. Ceram. Int. 2020, 46, 20788–20797. [Google Scholar] [CrossRef]
- Zhang, X.; Ai, Z.; Jia, F.; Zhang, L.; Fan, X.; Zou, Z. Selective synthesis and visible-light photocatalytic activities of BiVO4 with different crystalline phases. Mater. Chem. Phys. 2007, 103, 162–167. [Google Scholar] [CrossRef]
- Yu, J.; Zhang, Y.; Kudo, A. Synthesis and photocatalytic performances of BiVO4 by ammonia co-precipitation process. J. Solid State Chem. 2009, 182, 223–228. [Google Scholar] [CrossRef]
- de la Cruz, A.M.; Pérez, U.M.G. Photocatalytic properties of BiVO4 prepared by the co-precipitation method: Degradation of rhodamine B and possible reaction mechanisms under visible irradiation. Mater. Res. Bull. 2010, 45, 135–141. [Google Scholar] [CrossRef]
- Wan, Y.; Wang, S.; Luo, W.; Zhao, L. Impact of preparative pH on the morphology and photocatalytic activity of BiVO4. Int. J. Photoenergy 2012, 2012, 392865. [Google Scholar] [CrossRef]
- Chang, Y.-K.; Wu, Y.-S.; Lu, C.-S.; Lin, P.-F.; Wu, T.-Y. Photodegradation of alachlor using BiVO4 photocatalyst under visible light irradiation. Water Air Soil Pollut. 2015, 226, 194. [Google Scholar] [CrossRef]
- Hazarika, M.; Lutukurthi, D.N.V.V.K.; Ra, V.K. Photocatalytic activity of Ho3+-Yb3+ activated BiVO4 upconverting phosphors. J. Alloys Compd. 2024, 1002, 175453. [Google Scholar] [CrossRef]
- Ahmed, T.; Zhang, H.; Gao, Y.-Y.; Xu, H.; Zhang, Y. Surfactant-free synthesis of m-BiVO4 nanoribbons and enhanced visible-light photocatalytic properties. Mater. Res. Bull. 2018, 99, 298–305. [Google Scholar] [CrossRef]
- Deng, Y.; Huang, R.; Li, X.; Wang, Y.; Tian, J.; Zhu, M.; Gong, X. Surfactants modulating of BiVO4 on photocatalytic property as a regulation of surface free energy. Langmuir 2024, 40, 26540–26550. [Google Scholar] [CrossRef] [PubMed]
- Helal, A.; El-Sheikh, S.M.; Yu, J.; Eid, A.I.; El-Haka, S.A.; Samra, S.E. Novel synthesis of BiVO4 using homogeneous precipitation and its enhanced photocatalytic activity. J. Nanopart. Res. 2020, 22, 132. [Google Scholar] [CrossRef]
- Montañés, L.; Mesa, C.A.; Gutiérrez-Blanco, A.; Robles, C.; Julián-López, B.; Giménez, S. Facile surfactant-assisted synthesis of BiVO4 nanoparticulate films for solar water splitting. Catalysts 2021, 11, 1244. [Google Scholar] [CrossRef]
- Zhansheng, W.; Xue, Y.; He, X.; Li, Y.; Yang, X.; Wu, Z.; Cravotto, G. Surfactants-assisted preparation of BiVO4 with novel morphologies via microwave method and CdS decoration for enhanced photocatalytic properties. J. Hazard. Mater. 2020, 387, 122019. [Google Scholar] [CrossRef]
- Liu, J.; Li, B.; Kong, L.; Xiao, Q.; Huang, S. Surfactants-assisted morphological regulation of BiVO4 nanostructures for photocatalytic degradation of organic pollutants in wastewater. J. Phys. Chem. Solids 2023, 172, 111079. [Google Scholar] [CrossRef]
- Cheng, C.; Tan, H.; Zhu, W.; Liu, L.; Chen, K.; Yan, J. The transition of tetragonal to monoclinic phase in BiVO4 coupled with peroxymonosulfate for photocatalytic degradation of tetracycline hydrochloride. Environ. Res. 2025, 267, 120631. [Google Scholar] [CrossRef]
- Polo, A.; Dozzi, M.V.; Marra, G.; Sivula, K.; Selli, E. Improving the photoelectrocatalytic efficiency of CuWO4 through molybdenum for tungsten substitution and coupling with BiVO4. Sustain. Energy Fuels 2024, 8, 3182–3191. [Google Scholar] [CrossRef]
- Zhang, X.; Chen, F.; Tang, Y.; Liu, Y.; Wang, X. A rapid microwave synthesis of nanoscale BiVO4/Bi2O3@SiO2 with large specific surface area and excellent visible-light-driven activity. Desalin. Water Treat. 2019, 152, 99–107. [Google Scholar] [CrossRef]
- Chen, F.; Zhang, X.; Tang, Y.; Wang, X.; Shu, K. Facile and rapid synthesis of a novel spindle-like heterojunction BiVO4 showing enhanced visible-light-driven photoactivity. RSC Adv. 2020, 10, 5234–5240. [Google Scholar] [CrossRef] [PubMed]
- Sanchez-Martınez, D.; Hernandez-Uresti, D.B.; Torres-Martinez, L.; Mejia-Rosales, M.S. Photocatalytic properties of BiVO4 synthesized by microwave-assisted hydrothermal method under simulated sunlight irradiation. Res. Chem. Intermed. 2015, 41, 8839–8854. [Google Scholar] [CrossRef]
- Tan, G.; Zhang, L.; Ren, H.; Wei, S.; Huang, J.; Xia, A. Effects of pH on the hierarchical structures and photocatalytic performance of BiVO4 powders prepared via the microwave hydrothermal method. ACS Appl. Mater. Interfaces 2013, 5, 5186–5193. [Google Scholar] [CrossRef] [PubMed]
- Zhang, L.; Tan, G.; Wei, S.; Ren, H.; Xia, A.; Luo, Y. Microwave hydrothermal synthesis and photocatalytic properties of TiO2/BiVO4 composite photocatalysts. Ceram. Int. 2013, 39, 8597–8604. [Google Scholar] [CrossRef]
- Chen, S.-H.; Jiang, Y.-S.; Lin, H. Easy synthesis of BiVO4 for photocatalytic overall water splitting. ACS Omega 2020, 5, 8927–8933. [Google Scholar] [CrossRef]
- Kshetri, Y.K.; Regmi, C.; Dhakal, D.R.; Kim, T.-H.; Kim, S.H.; Kim, H.-S.; Lee, S.W. Microwave hydrothermal synthesis and upconversion properties of BiVO4 nanoparticles. Nanotechnology 2020, 31, 244001. [Google Scholar] [CrossRef] [PubMed]
- Zhao, G.; Ding, J.; Zhou, F.; Zhao, Q.; Wang, K.; Chen, X.; Gao, Q. Insight into a novel microwave-assisted W doped BiVO4 self-assembled sphere with rich oxygen vacancies oriented on rGO (W-BiVO4-x/rGO) photocatalyst for efficient contaminants removal. Sep. Purif. Technol. 2021, 277, 119610. [Google Scholar] [CrossRef]
- Wang, X.; Liu, H.; Wang, J.; Chang, L.; Song, N.; Yan, Z.; Wan, X. Additive-free solvothermal preparation, characterization, and photocatalytic activity of 3D butterfly-like BiVO4. Res. Chem. Intermed. 2015, 41, 2465–2477. [Google Scholar] [CrossRef]
- Kamble, G.S.; Ling, Y.C. Solvothermal synthesis of facet-dependent BiVO4 photocatalyst with enhanced visible-light-driven photocatalytic degradation of organic pollutant: Assessment of toxicity by zebrafish embryo. Sci. Rep. 2020, 10, 12993. [Google Scholar] [CrossRef]
- Pham, M.Q.; Ngo, T.M.; Nguyen, V.H.; Nong, L.X.; Vo, D.-V.N.; Tran, T.V.; Nguyen, T.-D.; Bui, X.-T.; Nguyen, T.D. Facile solvothermal synthesis of highly active monoclinic scheelite BiVO4 for photocatalytic degradation of methylene blue under white LED light irradiation. Arab. J. Chem. 2020, 13, 8388–8394. [Google Scholar] [CrossRef]
- Wang, S.; Zhao, L.; Huang, W.; Zhao, H.; Chen, J.; Cai, Q.; Jiang, X.; Lu, C.; Shi, W. Solvothermal synthesis of CoO/BiVO4 p-n heterojunction with micro-nano spherical structure for enhanced visible light photocatalytic activity towards degradation of tetracycline. Mater. Res. Bull. 2021, 135, 111161. [Google Scholar] [CrossRef]
- Wang, M.; Guo, Y.; Wang, Z.; Cui, H.; Sun, T.; Tang, Y. Simple glycerol-assisted and morphology controllable solvothermal synthesis of CeVO4/BiVO4 hierarchical hollow microspheres with enhanced photocatalytic activities. Mater. Chem. Front. 2021, 5, 6522–6529. [Google Scholar] [CrossRef]
- Li, B.; Wang, W.; Shi, J.; Zhang, Y.; Liu, X.; Dong, P.; Xi, X. Development of Z-scheme Bi5O7I/BiVO4 heterostructure for efficient photocatalytic water splitting activity. Colloids Surf. A Physicochem. Eng. Asp. 2025, 713, 136472. [Google Scholar] [CrossRef]
- Yu, S.; Su, C.; Xiao, Z.; Kuang, Y.; Gong, X.; He, X.; Liu, J.; Jin, Q.; Sun, Z. Tuning surface hydrophilicity of a BiVO4 photoanode through interface engineering for efficient PEC water splitting. RSC Adv. 2025, 15, 815–823. [Google Scholar] [CrossRef]
- Nguyen, T.D.; Cao, V.D.; Nguyen, V.H.; Nong, L.X.; Luu, T.D.; Vo, D.-V.N.; Do, S.T.; Lam, T.D. Synthesized BiVO4 was by the co-precipitation method for Rhodamine B degradation under visible light. IOP Conf. Ser. Mater. Sci. Eng. 2019, 542, 012058. [Google Scholar] [CrossRef]
- Vinothkumar, V.; Sangili, A.; Chen, S.-M.; Abinaya, M. Additive-free synthesis of BiVO4 microspheres as an electrochemical sensor for determination of antituberculosis drug rifampicin. Colloids Surf. A Physicochem. Eng. Asp. 2021, 624, 126849. [Google Scholar] [CrossRef]
- Riapanitra, A.; Setyaningtyas, T.; Haryanto, M.J.; Haryadinaru, G.H. Hydrothermal and coprecipitation synthesis design of BiVO4 for Methylene blue degradation. J. Ris. Kim. 2025, 16, 20–32. [Google Scholar] [CrossRef]
- Xie, Y.; Wu, H.; Luo, J.; Zhang, S.; Wang, L.; Wang, X.; Ma, Y.; Ning, P. Phase transition guided V2O5/β-Bi2O3 Z-scheme heterojunctions for efficient photocatalytic Hg0 oxidation. Sep. Purif. Technol. 2024, 330, 125318. [Google Scholar] [CrossRef]
- Phu, N.D.; Hoang, L.H.; Vu, P.K.; Kong, M.-H.; Chen, X.-B.; Wen, H.C.W.; Chou, C. Control of crystal phase of BiVO4 nanoparticles synthesized by microwave assisted method. J. Mater. Sci. Mater. Electron. 2016, 27, 6452–6456. [Google Scholar] [CrossRef]
- Sun, Q.; Qiao, F.; Zhou, T. CTAB assisted hydrothermal synthesis of oxygen vacancy enriched BiVO4 for enhanced photocatalytic hydrogen production. CrystEngComm 2025, 27, 948–955. [Google Scholar] [CrossRef]
- Yan, M.; Yan, Y.; Wu, Y.; Shi, W.; Hua, Y. Microwave-assisted synthesis of monoclinic–tetragonal BiVO4 heterojunctions with enhanced visible-light-driven photocatalytic degradation of tetracycline. RSC Adv. 2015, 5, 90255–90264. [Google Scholar] [CrossRef]
- Shafi, I.; Liang, E.; Li, B. Self-assembled BiVO4 nanorods: A fascinating electrode material for highly efficient pseudocapacitors and electrochemical nitrite sensors. J. Phys. Chem. Solids 2022, 162, 110517. [Google Scholar] [CrossRef]
- Heckel, S.; Wittmann, M.; Reid, M.; Villa, K.; Simmchen, J. An account on BiVO4 as photocatalytic active matter. Acc. Mater. Res. 2024, 5, 400–412. [Google Scholar] [CrossRef] [PubMed]
- Kudo, A.; Omori, K.; Kato, H. A novel aqueous process for preparation of crystal form-controlled and highly crystalline BiVO4 powder from layered vanadates at room temperature and its photocatalytic and photophysical properties. J. Am. Chem. Soc. 1999, 121, 11459–11467. [Google Scholar] [CrossRef]
- Ribeiro, F.W.P.; Gromboni, M.F.; Marken, F.; Mascaro, L.H. Photoelectrocatalytic properties of BiVO4 prepared with different alcohol solvents. Int. J. Hydrog. Energy 2016, 41, 17380–17389. [Google Scholar] [CrossRef]
- Liu, Y.; Ma, J.; Liu, Z.; Dai, C.; Song, Z.; Sun, Y.; Fang, J.; Zhao, J. Low-temperature synthesis of BiVO4 crystallites in molten salt medium and their UV–vis absorption. Ceram. Int. 2010, 36, 2073–2077. [Google Scholar] [CrossRef]
- Cheng, B.; Lou, H.; Zeng, Z.; Liu, Y.; Zeng, Q. Structural phase transition in BiVO4 nanosheets under high pressure. J. Phys. Chem. C 2024, 128, 12267–12273. [Google Scholar] [CrossRef]
- Zhao, Z.; Ling, Q.; Deng, S.; Li, Z.; Lv, J.; Yang, L.; Cao, C.; Sun, Z.; Zhang, M. Photocatalytic degradation of tetracycline hydrochloride using a BiVO4/MIL-88B(Fe) heterojunction. New J. Chem. 2024, 48, 9442–9456. [Google Scholar] [CrossRef]
- Miersch, L.; Rüffer, T.; Schlesinger, M.; Lang, H.; Mehring, M. Hydrolysis studies on bismuth nitrate: Synthesis and crystallization of four novel polynuclear basic bismuth nitrates. Inorg. Chem. 2012, 51, 9376–9384. [Google Scholar] [CrossRef]
- Pang, J.; Han, Q.; Liu, W.; Shen, Z.; Wang, X.; Zhu, J. Two basic bismuth nitrates: [Bi6O6(OH)2](NO3)4 2H2O with superior photodegradation activity for rhodamine B and [Bi6O5(OH)3](NO3)5·3H2O with ultrahigh adsorption capacity for methyl orange. App. Surf. Sci. 2017, 422, 283–294. [Google Scholar] [CrossRef]
- Dolić, S.D.; Jovanović, D.J.; Smits, K.; Babić, B.; Marinović-Cincović, M.; Porobić, S.; Dramićanin, M.D. A comparative study of photocatalytically active nanocrystalline tetragonal zyrcon-type and monoclinic scheelite-type bismuth vanadate. Ceram. Int. 2018, 44, 17953–17961. [Google Scholar] [CrossRef]
- Dolić, S.D.; Jovanović, D.J.; Štrbac, D.; Đačanin Far, L.J.; Dramićanin, M.D. Improved coloristic properties and high NIR reflectance of environment-friendly yellow pigments based on bismuth vanadate. Ceram. Int. 2018, 44, 22731–22737. [Google Scholar] [CrossRef]
- Marinković, D.; Righini, G.C.; Ferrari, M. Synthesis, optical, and photocatalytic properties of the BiVO4 semiconductor nanoparticles with tetragonal zircon-type structure. Photonics 2025, 12, 438. [Google Scholar] [CrossRef]
- Nguyena, T.D.; Hong, S.-S. Facile solvothermal synthesis of monoclinic-tetragonal heterostructured BiVO4 for photodegradation of rhodamine B. Catal. Commun. 2020, 136, 105920. [Google Scholar] [CrossRef]
- Esmaili, Z.; Sadeghian, Z.; Ashrafizadeh, S.N. Tailoring of BiVO4 morphology for efficient antifouling of visible-light-driven photocatalytic ceramic membranes for oily wastewater treatment. J. Water Process Eng. 2024, 67, 106145. [Google Scholar] [CrossRef]
- Li, J.-Q.; Guo, Z.-Y.; Wang, D.-F.; Lui, H.; Du, J.; Zhu, Z.-F. Effects of pH value on the surface morphology of BiVO4 microspheres and removal of methylene blue under visible light. J. Exp. Nanosci. 2014, 9, 616–624. [Google Scholar] [CrossRef]
- Huang, J.G.; Wang, B.; Pang, S.; Zhang, X.Y.; Yang, X.Y.; Guo, X.T.; Wang, X.S. Effects of pH value and hydrothermal time on the structure and photocatalytic activity of monoclinic-scheelite BiVO4. Optoelectron. Adv. Mater. Rapid Commun. 2015, 9, 1273–1279. [Google Scholar]
- Dong, S.; Xia, L.; Zhang, F.; Li, F.; Wang, Y.; Cui, L.; Feng, J.; Sun, J. Effects of pH value and hydrothermal treatment on the microstructure and natural-sunlight photocatalytic performance of ZnSn(OH)6 photocatalyst. J. Alloys Compd. 2019, 810, 151955. [Google Scholar] [CrossRef]
- Sun, M.; Guo, P.; Wang, M.; Ren, F. The effect of pH on the photocatalytic performance of BiVO4 for phenol mine sewage degradation under visible light. Optik 2019, 179, 672–679. [Google Scholar] [CrossRef]
- Kim, M.-W.; Samuel, E.; Kim, K.; Yoon, H.; Joshi, B.; Swihart, M.T.; Yoon, S.S. Tuning the morphology of electrosprayed BiVO4 from nanopillars to nanoferns via pH control for solar water splitting. J. Alloys Compd. 2018, 769, 193–200. [Google Scholar] [CrossRef]
- Wang, L.; Su, J.; Guo, L. Self-assembly synthesis of monodisperse BiVO4 nanosphere via a hybrid strategy for photoelectrochemical water splitting. ChemCatChem 2020, 12, 5269–5275. [Google Scholar] [CrossRef]
- Li, F.; Yang, C.; Li, Q.; Cao, W.; Li, T. The pH-controlled morphology transition of BiVO4 photocatalysts from microparticles to hollow microspheres. Mater. Lett. 2015, 145, 52–55. [Google Scholar] [CrossRef]
- Sun, W.; Xie, M.; Jing, L.; Luan, Y.; Fu, H. Synthesis of large surface area nano-sized BiVO4 by an EDTA-modified hydrothermal process and its enhanced visible photocatalytic activity. J. Solid State Chem. 2011, 184, 3050–3054. [Google Scholar] [CrossRef]
- Mao, J.; Wu, Q.; Tao, F.; Xu, W.; Hong, T.; Dong, Y. Facile fabrication of porous BiVO4 hollow spheres with improved visible-light photocatalytic properties. RSC Adv. 2020, 10, 6395–6404. [Google Scholar] [CrossRef]
- Yin, W.; Wang, W.; Shang, M.; Zhou, L.; Sun, S.; Wang, L. BiVO4 hollow nanospheres: Anchoring synthesis, growth mechanism, and their application in photocatalysis. EurJIC 2009, 2009, 4379–4384. [Google Scholar] [CrossRef]
- Dong, L.; Guo, S.; Zhu, S.; Xu, D.; Zhang, L.; Huo, M.; Yang, X. Sunlight responsive BiVO4 photocatalyst: Effects of pH on L-cysteine-assisted hydrothermal treatment and enhanced degradation of ofloxacin. Catal. Commun. 2011, 16, 250–254. [Google Scholar] [CrossRef]
- Xia, G.; Ye, J. Synthesis of bismuth vanadate nanoplates with exposed {001} facets and enhanced visible-light photocatalytic properties. Chem. Commun. 2010, 46, 1893–1895. [Google Scholar] [CrossRef] [PubMed]
- Ma, Y.; Jiang, H.; Zhang, X.; Xing, J.; Guan, Y. Synthesis of hierarchical m-BiVO4 particles via hydro-solvothermal method and their photocatalytic properties. Ceram. Int. 2014, 4, 16485–16493. [Google Scholar] [CrossRef]
- Chen, L.; Wang, J.; Meng, D.; Xing, Y.; Tian, X.; Yu, X.; Xu, K.; Wu, X. Effects of citric acid and urea on the structural and morphological characteristics of BiVO4 synthesized by the sol–gel combustion method. J. Sol-Gel Sci. Technol. 2015, 76, 562–571. [Google Scholar] [CrossRef]
- Adán, C.; Marugán, J.; Obregón, S.; Colón, G. Photocatalytic activity of bismuth vanadates under UV-A and visible light irradiation: Inactivation of Escherichia coli vs oxidation of methanol. Catal. Today 2015, 240, 93–99. [Google Scholar] [CrossRef]
- Liu, X.; Chen, W.; Wang, W.; Jiang, Y.; Cao, K.; Jiao, Z. F-regulate the preparation of polyhedral BiVO4 enclosed by high-index facet and enhance its photocatalytic activity. J. Colloid Interface Sci. 2022, 606, 393–405. [Google Scholar] [CrossRef] [PubMed]
- Ravidhas, C.; Josephine, A.J.; Sudhagar, P.; Devadoss, A.; Terashima, C.; Nakata, K.; Fujishima, A.; Raj, A.M.E.; Sanjeeviraja, C.; Pitchaimuthu, S. Facile synthesis of nanostructured monoclinic bismuth vanadate by a co-precipitation method: Structural, optical and photocatalytic properties. Mat. Sci. Semicon. Proc. 2015, 30, 343–351. [Google Scholar] [CrossRef]
- Zhang, Y.; Li, G.; Yang, X.; Yang, H.; Lu, Z.; Chen, R. Monoclinic BiVO4 micro-/nanostructures: Microwave and ultrasonic wave combined synthesis and their visible-light photocatalytic activities. J. Alloys Compd. 2013, 551, 544–550. [Google Scholar] [CrossRef]
- Lin, X.; Yu, L.; Yan, L.; Li, H.; Yan, Y.; Liu, C.; Zhai, H. Visible light photocatalytic activity of BiVO4 particles with different morphologies. Solid State Sci. 2014, 32, 61–66. [Google Scholar] [CrossRef]
- Zhang, H.M.; Liu, J.B.; Wang, H.; Zhang, W.X.; Yan, H. Rapid microwave-assisted synthesis of phase controlled BiVO4 nanocrystals and research on photocatalytic properties under visible light irradiation. J. Nanopart. Res. 2008, 10, 767–774. [Google Scholar] [CrossRef]
- Trinh, D.T.T.; Khanitchaidecha, W.; Channei, D.; Nakaruk, A. Synthesis, characterization and environmental applications of bismuth vanadate. Res. Chem. Intermed. 2019, 45, 5217–5259. [Google Scholar] [CrossRef]
- Wu, S.M.; Jing, Q.; Feng, X.; Chen, L. BiVO4 microstructures with various morphologies: Synthesis and characterization. Appl. Surf. Sci. 2018, 427, 525–532. [Google Scholar] [CrossRef]
- Qurashi, M.M.; Barnes, W.H.A. Preliminary structure for pucherite, BiVO4. Am. Mineral. 1952, 37, 423–426. [Google Scholar]
- Zhou, D.; Pang, L.X.; Wang, D.W.; Reaney, I.M. BiVO4 based high K microwave dielectric materials: A review. J. Mater. Chem. C 2018, 6, 9290–9313. [Google Scholar] [CrossRef]
- Jovanović, D.J.; Chiappini, A.; Zur, L.; Gavrilović, T.V.; Tran, T.N.L.; Chiasera, A.; Lukowiak, A.; Smits, K.; Dramićanin, M.D.; Ferrari, M. Synthesis, structure and spectroscopic properties of luminescent GdVO4:Dy3+ and DyVO4 particles. Opt. Mater. 2018, 76, 308–316. [Google Scholar] [CrossRef]
- Sleight, A.W.; Chen, H.; Ferretti, A.; Cox, D.E. Crystal growth and structure of BiVO4. Mater. Res. Bull. 1979, 14, 1571–1581. [Google Scholar] [CrossRef]
- Tokunaga, S.; Kato, H.; Kudo, A. Selective preparation of monoclinic and tetragonal BiVO4 with scheelite structure and their photocatalytic properties. Chem. Mater. 2001, 13, 4624–4628. [Google Scholar] [CrossRef]
- Gea, J.; Wu, L.; Gab, L.; Niu, H.; Liu, M.; Zou, Y.; Wang, J.; Jin, J. Green light all the way: Triple modification synergistic modification effect to enhance the photoelectrochemical water oxidation performance of BiVO4 photoanode. J. Colloid Interface Sci. 2025, 677, 90–98. [Google Scholar] [CrossRef] [PubMed]
- Park, H.S.; Kweon, K.E.; Ye, H.; Paek, E.; Hwang, G.S.; Bard, A.J. Factors in the metal doping of BiVO4 for improved photoelectrocatalytic activity as studied by scanning electrochemical microscopy and first-principles density-functional calculation. J. Phys. Chem. C 2011, 115, 1787017879. [Google Scholar] [CrossRef]
- Abdellaoui, I.; Islam, M.M.; Remeika, M.; Higuchi, Y.; Kawaguchi, T.; Harada, T.; Budich, C.; Maeda, T.; Wada, T.; Ikeda, S.; et al. Photocarrier recombination dynamics in BiVO4 for visible light-driven water oxidation. J. Phys. Chem. C 2020, 124, 39623972. [Google Scholar] [CrossRef]
- Ravensbergen, J.; Abdi, F.F.; van Santen, J.H.; Frese, R.N.; Dam, B.; van de Krol, R.; Kennis, J.T.M. Unraveling the Carrier Dynamics of BiVO4: A femtosecond to microsecond transient absorption study. J. Phys. Chem. C 2014, 118, 2779327800. [Google Scholar] [CrossRef]
- Suzuki, Y.; Murthy, D.H.K.; Matsuzaki, H.; Furube, A.; Wang, Q.; Hisatomi, T.; Domen, K.; Seki, K. Rational interpretation of correlated kinetics of mobile and trapped charge carriers: Analysis of ultrafast carrier dynamics in BiVO4. J. Phys. Chem. C 2017, 121, 1904419052. [Google Scholar] [CrossRef]
- Ma, Y.; Pendlebury, S.R.; Reynal, A.; Formal, L.F.; Durrant, J.R. Dynamics of photo generated holes in undoped BiVO4 photoanodes for solar water oxidation. Chem. Sci. 2014, 5, 29642973. [Google Scholar] [CrossRef]
- Merupo, V.; Velumani, S.; Oza, G.; Makowska-Janusik, M.; Kassiba, A. Structural, electronic and optical features of molybdenum-doped bismuth vanadium oxide. Mater. Sci. Semicond. Process. 2015, 31, 618623. [Google Scholar] [CrossRef]
- Kalanur, S.S.; Seo, H. An experimental and density functional theory studies of Nb-doped BiVO4 photoanodes for enhanced solar water splitting. J. Catal. 2022, 410, 144–155. [Google Scholar] [CrossRef]
- Kunioku, H.; Higashi, M.; Tomita, O.; Yabuuchi, M.; Kato, D.; Fujito, H.; Kageyama, H.; Abe, R. Strong hybridization between Bi-6s and O-2p orbitals in Sillén–Aurivillius perovskite Bi4MO8X (M = Nb, Ta; X = Cl, Br), visible light photocatalysts enabling stable water oxidation. J. Mater. Chem. A 2018, 6, 3100–3107. [Google Scholar] [CrossRef]
- Tolod, K.R.; Hernández, S.; Russo, N. Recent advances in the BiVO4 photocatalyst for sun-driven water oxidation: Top-performing photoanodes and scale-up challenges. Catalysts 2017, 7, 13. [Google Scholar] [CrossRef]
- Pramila, S.; Mallikarjunaswamy, C.; Ranganatha, V.L.; Nagaraju, G. BiVO4 nanoballs: A simple precipitation pathway, promising electrochemical sensor, and photodegradation under visible light. Ionics 2024, 30, 2819–2838. [Google Scholar] [CrossRef]
- Aghakhaninejad, S.; Rahimi, R.; Zargari, S. Application of BiVO4 nanocomposite for photodegradation of methyl orange. Proceedings 2019, 9, 52. [Google Scholar] [CrossRef]
- Sobahi, T.R. Application of BiVO4-MWCNT nanocomposites for boosted photocatalytic oxidation of atrazine under visible light. Appl. Nanosci. 2021, 11, 2811–2822. [Google Scholar] [CrossRef]
- Chopade, A.S.; Kolhe, N.D.; Walekar, L.S.; Kadam, A.N.; Patil, V.A.; Al-Enizi, A.M.; Tamboli, M.S.; Mhamane, D.S.; Mali, M.G. Chemical bath assisted construction of CuO/BiVO4 p-n heterojunction photocatalyst for visible light driven rapid removal of MB and Cr(VI). Colloids Surf. A Physicochem. Eng. Asp. 2024, 700, 134665. [Google Scholar] [CrossRef]
- Liapun, V.; Hanif, M.B.; Sihor, M.; Vislocka, X.; Pandiaraj, S.; Unnikrishnan, V.K.; Thirunavukkarasu, G.K.; Edelmannová, M.F.; Reli, M.; Monfort, O.; et al. Versatile application of BiVO4/TiO2 S-scheme photocatalyst: Photocatalytic CO2 and Cr(VI) reduction. Chemosphere 2023, 337, 139397. [Google Scholar] [CrossRef]
- Jing, Q.; Feng, X.; Zhao, X.; Duan, Z.; Pan, J.; Chen, L.; Liu, Y. Bi/BiVO4 chainlike hollow microstructures: Synthesis, characterization, and application as visible-light-active photocatalysts. ACS Appl. Nano Mater. 2018, 1, 2653–2661. [Google Scholar] [CrossRef]
- Shi, H.; Li, C.; Zheng, R.; Wang, L.; Wang, W.; Bian, J.; Meng, X. Synergistic effect of oxygen vacancies and built-in electric field in GdCrO3/BiVO4 composites for boosted photocatalytic reduction of nitrate in water. J. Clean. Prod. 2023, 407, 137088. [Google Scholar] [CrossRef]
- Jeon, H.C.; Kumar, G.M.; Lee, D.J.; Sekar, S.; Kim, D.Y.; Ilanchezhiyan, P. Fabrication of 2D/2D InVO4/BiVO4 heterojunction with synergistic effects for enhanced photocatalytic degradation and photoelectrochemical applications. Int. J. Energy Res. 2024, 1, 1–12. [Google Scholar] [CrossRef]
- Orimolade, B.O.; Arotiba, O.A. Towards visible light driven photoelectrocatalysis for water treatment: Application of a FTO/BiVO4/Ag2S heterojunction anode for the removal of emerging pharmaceutical pollutants. Sci. Rep. 2020, 10, 5348. [Google Scholar] [CrossRef]
- Alhaddad, M.; Amin, M.S. Removal of ciprofloxacin applying Pt@BiVO4-g-C3N4 nanocomposite under visible light. Opt. Mater. 2022, 124, 111976. [Google Scholar] [CrossRef]
- Kumar, M.; Gaur, A.; Chauhan, V.S.; Vaish, R.; Kebaili, I. Tribocatalytic dye degradation using BiVO4. Ceram. Int. 2024, 50, 8360–8369. [Google Scholar] [CrossRef]
- Zhu, M.; Yang, S.; Wang, D.; Hogan, J.; Sadrzadeh, M. CTAC-assisted monoclinic BiVO4 with oxygen defects for efficient photocatalytic performances: A combined experimental and DFT study. J. Alloys Compd. 2024, 990, 174404. [Google Scholar] [CrossRef]
- Ge, Y.-D.; Xing, M.-Y.; Zhang, H.-S.; Zhou, X.-Y.; Zhang, L.; Wang, X.; Xu, L. Study on the development of an innovative type-II sonocatalyst of BiVO4/FeVO4 and its application in sonocatalytic removal of tetracycline. J. Alloys Compd. 2025, 1018, 179089. [Google Scholar] [CrossRef]
- Obregón, S.; Caballero, A.; Colón, G. Hydrothermal synthesis of BiVO4: Structural and morphological influence on the photocatalytic activity. Appl. Catal. B Environ. 2012, 117–118, 59–66. [Google Scholar] [CrossRef]
- Ying, Y.; Tao, F.; Hong, T.; Wang, L. Controlled fabrication of bismuth vanadium oxide hierarchical microtubes with enhanced visible light photocatalytic activity. Mat. Sci. Semicon. Proc. 2015, 32, 82–89. [Google Scholar] [CrossRef]
- Lu, Y.; Luo, Y.-S.; Xiao, H.-M.; Fu, S.-Y. Novel core–shell structured BiVO4 hollow spheres with an ultra-high surface area as visible-light-driven catalyst. CrystEngComm 2014, 16, 6059–6065. [Google Scholar] [CrossRef]
- Cai, H.; Cheng, L.; Chen, H.; Dou, R.; Chen, J.; Zhao, Y.; Li, F.; Fang, Z. Facile phase control and photocatalytic performance of BiVO4 crystals for methylene blue degradation. Int. J. Environ. Res. Public Health 2023, 20, 3093. [Google Scholar] [CrossRef]
- Malathi, A.; Madhavan, J.; Ashokkumar, M.; Arunachalam, P. A review on BiVO4 photocatalyst: Activity enhancement methods for solar photocatalytic applications. Appl. Catal. A Gen. 2018, 555, 47–74. [Google Scholar] [CrossRef]
- Roškarič, M.; Žerjav, G.; Finšgar, M.; Zavašnik, J.; Pintar, A. Influence of the calcination duration of g-C3N4/TiO2 “veggie-toast-like” photocatalyst on the visible-light triggered photocatalytic oxidation of bisphenol A. J. Alloys Compd. 2023, 947, 169585. [Google Scholar] [CrossRef]
- Vasilić, R.; Stojadinović, S.; Radić, N.; Stefanov, P.; Dohčević-Mitrović, Z.; Grbić, B. One-step preparation and photocatalytic performance of vanadium doped TiO2 coatings. Mater. Chem. Phys. 2015, 151, 337–344. [Google Scholar] [CrossRef]
- Liang, J.; Wang, J.; Yu, K.; Song, K.; Wang, X.; Liu, W.; Hou, J.; Liang, C. Enhanced photocatalytic performance of Nd3+-doped TiO2 nanosphere under visible light. Chem. Phys. 2020, 528, 110538. [Google Scholar] [CrossRef]
- Ücker, C.L.; Goetzke, V.; Almeida, S.R.; Moreira, E.C.; Ferrer, M.M.; Jardim, P.L.G.; Moreira, M.L.; Raubach, C.W.; Cava, S. Photocatalytic degradation of rhodamine B using Nb2O5 synthesized with different niobium precursors: Factorial design of experiments. Ceram. Int. 2021, 47, 20570–20578. [Google Scholar] [CrossRef]
- An, G.W.; Mahadik, M.A.; Piao, G.; Chae, W.-S.; Park, H.; Cho, M.; Chung, H.-S.; Jang, J.S. Hierarchical TiO2@In2O3 heteroarchitecture photoanodes: Mechanistic study on interfacial charge carrier dynamics through water splitting and organic decomposition. Appl. Surf. Sci. 2019, 480, 1–12. [Google Scholar] [CrossRef]
- Trandafilović, L.V.; Jovanović, D.J.; Zhang, X.; Ptasińska, S.; Dramićanin, M.D. Enhanced photocatalytic degradation of methylene blue and methyl orange by ZnO: Eu nanoparticles. Appl. Catal. B Environ. 2017, 203, 740–752. [Google Scholar] [CrossRef]
- Ekthammathat, N.; Phuruangrat, A.; Thongtem, S.; Thongtem, T. Synthesis, characterization and antibacterial activity of BiVO4 microstructure. Russ. J. Phys. Chem. 2018, 92, 1036–1040. [Google Scholar] [CrossRef]
- Sharma, R.; Uma; Singh, S.; Verma, A.; Khanuja, M. Visible light induced bactericidal and photocatalytic activity of hydrothermally synthesized BiVO4 nano-octahedrals. J. Photochem. Photobiol. B Biol. 2016, 162, 266–272. [Google Scholar] [CrossRef]
- Saleem, A.; Ahmed, T.; Ammar, M.; Zhang, H.; Xu, H.; Tabassum, R. Direct growth of m-BiVO4@carbon fibers for highly efficient and recyclable photocatalytic and antibacterial applications. J. Photochem. Photobiol. B Biol. 2020, 213, 112070. [Google Scholar] [CrossRef]
- Iqbal, T.; Qureshi, M.T.; Shahzad, R.; Afsheen, S.; Kausar, S.; Yunus, G.; Mansha, M.S.; Aamir, L.; Munir, R.M.; El-Serehy, H.A.; et al. Synergistic impacts of novel tantalum doping in BiVO4 for effective photocatalytic applications, antimicrobial activity, and antioxidant aspect. Inorg. Chem. Commun. 2024, 170, 113365. [Google Scholar] [CrossRef]
- Bulut, D.T. Exploring the dual role of BiVO4 nanoparticles: Unveiling enhanced antimicrobial efficacy and photocatalytic performance. J. Sol-Gel Sci. Technol. 2025, 114, 198–222. [Google Scholar] [CrossRef]
- Ganeshbabu, M.; Kannan, N.; Venkatesh, P.S.; Paulraj, G.; Jeganathan, K.; Ali, D.M. Synthesis and characterization of BiVO4 nanoparticles for environmental applications. RSC Adv. 2020, 10, 18315–18322. [Google Scholar] [CrossRef]
- Gomez-Polo, C.; Larumbe, S.; Gil, A.; Muñoz, D.; Fernández, L.R.; Barquín, L.F.; García-Prieto, A.; Fdez-Gubieda, M.L.; Muela, A. Improved photocatalytic and antibacterial performance of Cr doped TiO2 nanoparticles. Surf. Interfac. 2021, 22, 100867. [Google Scholar] [CrossRef]
- Wafi, A.; Szabó-Bárdos, E.; Horváth, O.; Pósfai, M.; Makó, É.; Juzsakova, T.; Fónagy, O. The photocatalytic and antibacterial performance of nitrogen-doped TiO2: Surface-structure dependence and silver-deposition effect. Nanomaterials 2020, 10, 2261. [Google Scholar] [CrossRef] [PubMed]
- Madhavi, B.; Reddy, A.S.S.; Prasad, P.S.; Prasad, A.; Devi, P.P.K.; Kumar, V.R.; Veeraiah, N. The impact of Nb2O5 on in-vitro bioactivity and antibacterial activity of CaF2–CaO–B2O3–P2O5–SrO glass system. Ceram. Int. 2021, 47, 28328–28337. [Google Scholar] [CrossRef]
- Kim, S.; Park, H.; Pandey, S.; Jeong, D.; Lee, C.-T.; Do, J.Y.; Park, S.-M.; Kang, M. Effective antibacterial/photocatalytic activity of ZnO nanomaterials synthesized under low temperature and alkaline conditions. Nanomaterials 2022, 12, 4417. [Google Scholar] [CrossRef]
- Abid, H.N.; Ahmed, D.S.; Al-keisy, A.H. Constructed p-2D/n-2D BiOCl/BiVO4 nanoheterostructure for photocatalytic antibacterial activity. ECS Trans. 2022, 107, 2283. [Google Scholar] [CrossRef]
- Li, B.; Gao, X.; Qu, J.; Xiong, F.; Xuan, H.; Jin, Y.; Yuan, H. Visible-light-driven antimicrobial activity and mechanism of polydopamine-reduced graphene oxide/BiVO4 composite. Int. J. Mol. Sci. 2022, 23, 7712. [Google Scholar] [CrossRef] [PubMed]
- Ran, J.; Chen, H.; Bai, X.; Bi, S.; Jiang, H.; Cai, G.; Cheng, D.; Wang, X. Immobilizing CuO/BiVO4 nanocomposite on PDA-templated cotton fabric for visible light photocatalysis, antimicrobial activity and UV protection. Appl. Surf. Sci. 2019, 493, 1167–1176. [Google Scholar] [CrossRef]
- Wang, R.; Wu, Z.; Chen, X.; Cheng, B.; Ou, W. Water purification using a BiVO4/graphene oxide multifunctional hydrogel based on interfacial adsorption-enrichment and photocatalytic antibacterial activity. Ceram. Int. 2023, 49, 9657–9671. [Google Scholar] [CrossRef]
- Pramila, S.; Nagaraju, G.; Mallikarjunaswamy, C.; Latha, K.C.; Chandan, S.; Ramu, R.; Rashmi, V.; Ranganatha, V.L. Green synthesis of BiVO4 nanoparticles by microwave method using Aegle Marmelos juice as a fuel: Photocatalytic and antimicrobial study. Anal. Chem. Lett. 2020, 10, 298–306. [Google Scholar] [CrossRef]
- Wang, L.; Han, D.; Ni, S.; Ma, W.; Wang, W.; Niu, L. Photoelectrochemical device based on Mo-doped BiVO4 enables smart analysis of the global antioxidant capacity in food. Chem. Sci. 2015, 6, 6632–6638. [Google Scholar] [CrossRef]
- Han, F.; Luo, S.; Wu, Z.; Liang, Z.; Yang, W.; Han, D.; Sun, Z.; Liu, Z.; Niu, L. A label-free photoelectrochemical sensor based on BiVO4@graphene oxide hybrid for analysis of the antioxidant capacity in food. J. Electroanal. Chem. 2023, 946, 117713. [Google Scholar] [CrossRef]
- Li, Y.; Dai, X.; He, L.; Bu, Y. Crystal-reconstructed BiVO4 semiconductor photoelectrochemical sensor for ultra-sensitive tumor biomarker detection. J. Mater. Chem. B 2022, 10, 870–879. [Google Scholar] [CrossRef]
- Petruleviciene, M.; Savickaja, I.; Kovger-Jarosevic, J.; Skruodiene, M.; Juodkazyte, J.; Ramanavicius, S.; Ramanavicius, A. BiVO4-based photoelectrochemical sensors for the detection of diclofenac: The role of doping, electrolytes and applied potentials. Chemosensors 2024, 12, 249. [Google Scholar] [CrossRef]
- Wu, W.; Tan, Z.; Chen, X.; Chen, X.; Cheng, L.; Wu, H.; Li, P.; Zhang, Z. Carnation-like morphology of BiVO4-7 enables sensitive photoelectrochemical determination of Cr(VI) in the food and environment. Biosensors 2022, 12, 130. [Google Scholar] [CrossRef]
- Ye, C.; Xu, S.; Wu, Z.; Wang, M. Cu3(PO4)2/BiVO4 photoelectrochemical sensor for sensitive and selective determination of synthetic antioxidant propyl gallate. Anal. Bioanal. Chem. 2022, 414, 4139–4147. [Google Scholar] [CrossRef]
- Murugan, E.; Poongan, A. A new sensitive electrochemical sensor based on BiVO4/ZrO2@graphene modified GCE for concurrent sensing of acetaminophen, phenylephrine hydrochloride and cytosine in medications and human serum samples. Diam. Relat. Mater. 2022, 126, 109117. [Google Scholar] [CrossRef]
- Sarikaya, I.; Kaleoglu, E.; Çakar, S.; Soykan, C.; Özacar, M. An enhanced photosensitive sensor based on ITO/MWCNTs@polymercomposite@BiVO4 for quercetin detection. Biosensors 2023, 13, 729. [Google Scholar] [CrossRef] [PubMed]
- Niu, P.B.; Cao, Q.; Huang, L.; Zhou, C.H.; Ling, J.; Hu, R.; Yang, T. Wavelength-dependent photoelectrochemical sensor array based on Bi2WO6/TiO2 electrospun nanoheterojunction for multiple antioxidants identification and total antioxidant capacity analysis in natural tea. Microchem. J. 2024, 206, 111568. [Google Scholar] [CrossRef]
- Nurdin, M.; Maulidiyah, M.; Salim, L.O.A.; Muzakkar, M.Z.; Umar, A.A. High performance cypermethrin pesticide detection using anatase TiO2-carbon paste nanocomposites electrode. Microchem. J. 2019, 145, 756–761. [Google Scholar] [CrossRef]
- He, Q.; Liu, J.; Liu, X.; Li, G.; Deng, P.; Liang, J.; Chen, D. Sensitive and selective detection of tartrazine based on TiO2-electrochemically reduced graphene oxide composite-modified electrodes. Sensors 2018, 18, 1911. [Google Scholar] [CrossRef]
- Mai, Q.-D.; Thanh, D.C.; Anh, N.T.; Manh, T.V.; Bach, T.N.; Nguyen, H.-A.; Pham, A.-T.; Le, A.-T. Smart 3D Ag-decorated TiO2 nanostructure: An advanced synergistic SERS substrate for trace detection of analytes with diverse natures. Sens. Actuators B Chem. 2024, 410, 135651. [Google Scholar] [CrossRef]
- Bruce, J.; Bosnick, K.; Heidari, E.K. Pd-decorated ZnO nanoflowers as a promising gas sensor for the detection of meat spoilage. Sens. Actuators B Chem. 2022, 355, 131316. [Google Scholar] [CrossRef]
- Kumarage, G.W.C.; Panamaldeniya, S.A.; Maraloiu, V.A.; Dassanayake, B.S.; Gunawardhana, N.; Comini, E. Nb2O5 microcolumns for ethanol sensing. Sensors 2024, 24, 1851. [Google Scholar] [CrossRef] [PubMed]
- Mokrushin, A.S.; Simonenko, T.L.; Simonenko, N.P.; Gorobtsov, P.Y.; Kadyrov, N.C.; Simonenko, E.P.; Sevastyanov, V.G.; Kuznetsov, N.T. Chemoresistive gas-sensing properties of highly dispersed Nb2O5 obtained by programmable precipitation. J. Alloys Compd. 2021, 868, 159090. [Google Scholar] [CrossRef]
- Zhao, Z.; Wu, Z.; Lin, X.; Han, F.; Liang, Z.; Huang, L.; Dai, M.; Han, D.; Han, L.; Niu, L. A label-free PEC aptasensor platform based on g-C3N4/BiVO4 heterojunction for tetracycline detection in food analysis. Food Chem. 2023, 402, 134258. [Google Scholar] [CrossRef]
- Wang, S.; Li, C.; Qi, Y.; Zhang, J.; Wang, N.; Liu, M.; Zhang, B.; Cai, X.; Zhang, H.; Wei, S.; et al. Etched BiVO4 photocatalyst with charge separation efficiency exceeding 90%. Nat. Commun. 2025, 16, 3776. [Google Scholar] [CrossRef] [PubMed]
- Tao, X.; Zhao, Y.; Wang, S.; Li, C.; Li, R. Recent advances and perspectives for solar-driven water splitting using particulate photocatalysts. Chem. Soc. Rev. 2022, 51, 3561–3608. [Google Scholar] [CrossRef]
- Wang, S.; Wan, K.; Feng, J.; Yang, Y.; Wang, S. BiVO4 photoanodes with enhanced photoelectrochemical performance: Preparation, modification and emerging applications. J. Mater. Sci. Tech. 2025, 217, 182–220. [Google Scholar] [CrossRef]
- Huang, J.; Lin, T.; Lin, L.; Ma, G.; Zhang, Z.; Handschuh-Wang, S.; Meng, A.; Han, P.; He, B. Boosted charge transport efficiency for bismuth and oxygen dual vacancy-engineered BiVO4 photoanodes. ACS Appl. Energy Mater. 2024, 7, 10710–10720. [Google Scholar] [CrossRef]
- Liu, B.; Wang, X.; Zhang, Y.; Wan, K.; Xu, L.; Ma, S.; Zhao, R.; Wang, S.; Huang, W. Bismuth vacancies induced lattice strain in BiVO4 photoanodes boosting charge separation for water oxidation. Adv. Energy Mater. 2025, 15, 2403835. [Google Scholar] [CrossRef]
- Yi, Q.; Wang, H.; Lee, J.-M. BiVO4-based photoelectrochemical water splitting. ChemElectroChem 2025, 12, e202400600. [Google Scholar] [CrossRef]
- Wang, Z.; Li, C.; Domen, K. Recent developments in heterogeneous photocatalysts for solar-driven overall water splitting. Chem. Soc. Rev. 2019, 48, 2109–2125. [Google Scholar] [CrossRef]
- Nasir, J.A.; Munir, A.; Ahmad, N.; Haq, T.; Khan, Z.; Rehman, Z. Photocatalytic Z-scheme overall water splitting: Recent advances in theory and experiments. Adv. Mater. 2021, 33, 2105195. [Google Scholar] [CrossRef] [PubMed]
- Zhou, P.; Navid, I.A.; Ma, Y.; Xiao, Y.; Wang, P.; Ye, Z.; Zhou, B.; Sun, K.; Mi, Z. Solar-to-hydrogen efficiency of more than 9% in photocatalytic water splitting. Nature 2023, 613, 66–70. [Google Scholar] [CrossRef] [PubMed]
- Hwang, S.W.; Jeong, Y.J.; Tan, R.; Saravanan, I.; Han, H.S.; Kim, D.H.; Cho, I.S. Texture development and surface reconstruction of BiVO4 photoanode via one-pot hydrothermal reaction for enhanced photoelectrochemical water splitting. J. Adv. Ceram. 2025, 14, 9221043. [Google Scholar] [CrossRef]
- Chi, J.; Wei, Z.; Fang, W.; Yan, J.; Wang, J.; Zu, H.; Cheng, J.; Luo, H.; Ye, Z.; Liu, J.; et al. Octadecahedral BiVO4 with exposed high-reactivity {121} facets for enhanced photoelectrochemical water splitting. Appl. Catal. B Environ. 2025, 365, 124973. [Google Scholar] [CrossRef]
- Xiao, C.; Assavachin, S.; Hahn, W.; Wang, L.; van Benthem, K.; Osterloh, F.E. Flux synthesis of single crystal bismuth vanadate (BiVO4) nanowires and their visible light driven photocatalytic water oxidation properties. J. Mater. Chem. A 2025, 13, 7834–7844. [Google Scholar] [CrossRef]
- Veetil, S.P.; Vattakkoval, N.; Veedu, S.K.; Vijayan, B.K. Supercapacitor applications of cerium doped BiVO4 nanosheets as electrode materials. AIP Conf. Proc. 2025, 3198, 020131. [Google Scholar] [CrossRef]
- Wan, X.; Luo, X.; Lu, D.; Liu, G.; Fu, Y.; Cai, L.; Hu, C.; Wan, H. Controllable fabrication of Cu: BiVO4 nanostructures via a two-step electrodeposition strategy for efficient photoelectrochemical water splitting. J. Alloys Compd. 2025, 1010, 177903. [Google Scholar] [CrossRef]
- Wang, H.; Bai, Y.; Wang, R.; Fu, Y.; Mei, Q.; Bai, B.; Wang, Q. Boosting photoelectrochemical water splitting: Enhanced hole transport in BiVO4 photoanodes via interfacial coupling. Catal. Sci. Technol. 2025, 15, 405–415. [Google Scholar] [CrossRef]
- Li, Q.; Cui, X.; Liu, X.; Wang, W. Ti3C2 quantum dots decorated BiVO4 photoelectrode for both photoelectrochemical water splitting and H2O2 determination. J. Alloys Compd. 2025, 1011, 178399. [Google Scholar] [CrossRef]
- Li, H.; Lyu, M.; Lai, Y.; Cheng, X.; Dong, Z. For effective water splitting by inserting a p-type copper thiocyanate hole transfer layer between BiVO4 and Ni-doped FeOOH cocatalyst. Int. J. Hydrogen Energy 2025, 106, 1006–1015. [Google Scholar] [CrossRef]
- Saad, A.M.; Mady, A.H.; Sayed, M.S.; Kim, G.; Kim, M.; Kim, W.K. Boosting water oxidation kinetics of BiVO4 through a metal-organic co-catalyst enriched with phosphate groups (Co,Fe-NTMP): Insights from LMCT mechanism and DFT study. Appl. Catal. B Environ. Energy 2025, 370, 125163. [Google Scholar] [CrossRef]
- Kavitha, T.; Rojviroon, O.; Rajendran, R.; Rojviroon, T. Construction of hybrid 2D g-C3N4/BiVO4 photocatalyst decorated with RGO for enhancing the H2 production and photocatalytic degradation of antibiotics. J. Porous Mater. 2025, 32, 1457–1469. [Google Scholar] [CrossRef]
- Miao, Z.; Wang, R.; Li, X.; Sun, F.; Ge, M.; Huang, N.; Zhao, Y.; Chang, Z.; Wang, H. Photoreduced Ag nanoparticles-decorated BiVO4 nanoplates as photoanode boosting photoelectrochemical H2O2 fuel cell performance. J. Power Sources 2025, 629, 235998. [Google Scholar] [CrossRef]
- Andrei, V.; Chiang, Y.-H.; Rahaman, M.; Anaya, M.; Kang, T.; Ruggeri, E.; Stranks, S.D.; Reisner, E. Modular perovskite-BiVO4 artificial leaves towards syngas synthesis on a m2 scale. Energy Environ. Sci. 2025, 18, 3623–3632. [Google Scholar] [CrossRef]
- Fu, H.; Wu, Y.; Guo, Y.; Sakurai, T.; Zhang, Q.; Liu, Y.; Zheng, Z.; Cheng, H.; Wang, Z.; Huang, B.; et al. A scalable solar-driven photocatalytic system for separated H2 and O2 production from water. Nat. Commun. 2025, 16, 990. [Google Scholar] [CrossRef] [PubMed]
Disclaimer/Publisher’s Note: The statements, opinions and data contained in all publications are solely those of the individual author(s) and contributor(s) and not of MDPI and/or the editor(s). MDPI and/or the editor(s) disclaim responsibility for any injury to people or property resulting from any ideas, methods, instructions or products referred to in the content. |
© 2025 by the authors. Licensee MDPI, Basel, Switzerland. This article is an open access article distributed under the terms and conditions of the Creative Commons Attribution (CC BY) license (https://creativecommons.org/licenses/by/4.0/).